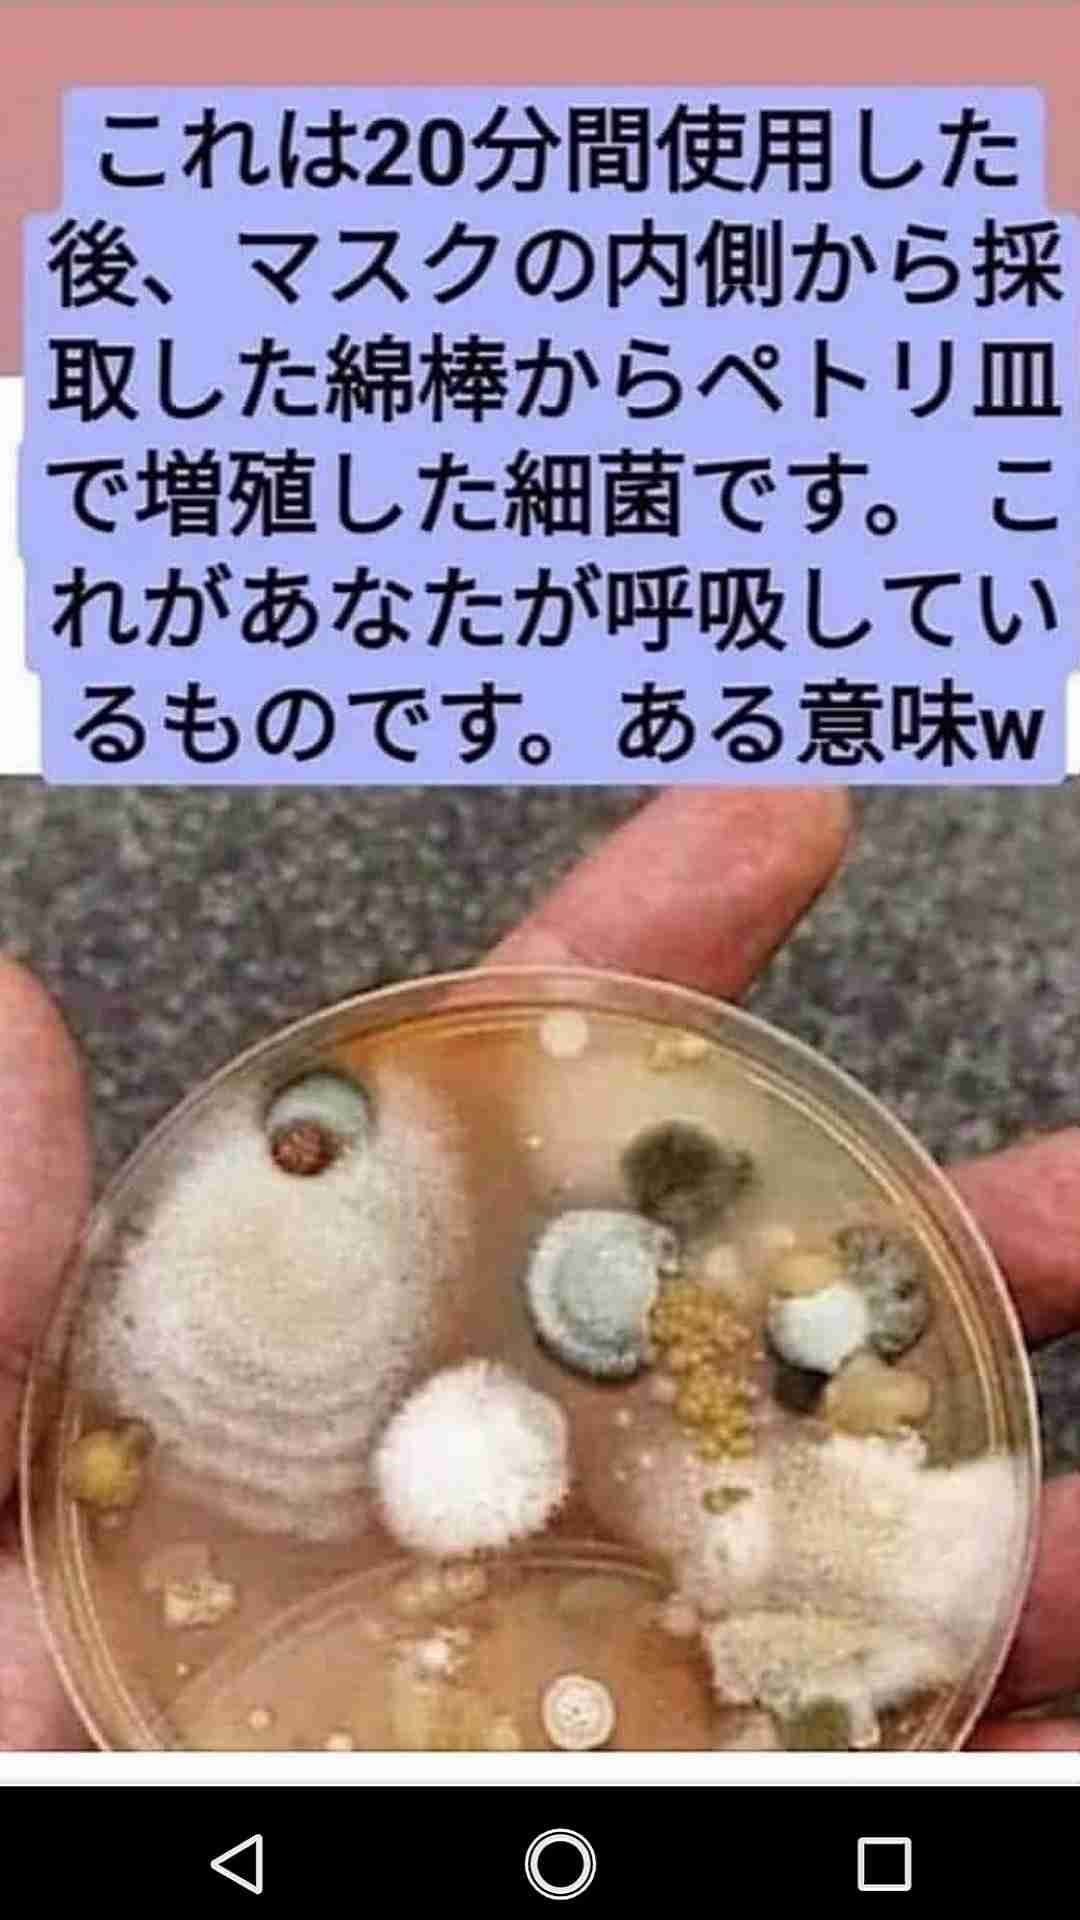
「屋外ではマスクをはずす」 東京都医師会が提案　段階的な感染対策解除も求める
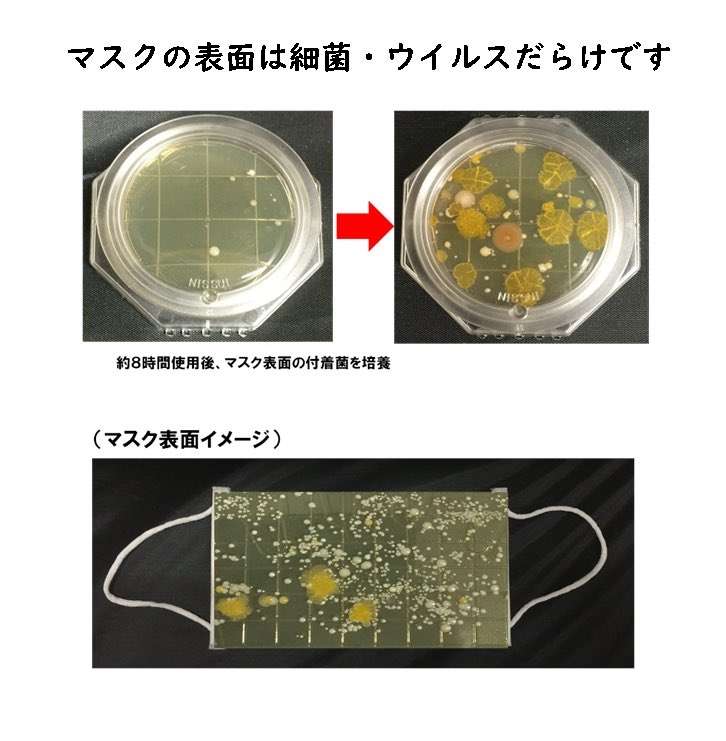
「屋外ではマスクをはずす」 東京都医師会が提案　段階的な感染対策解除も求める

-
3001. 匿名 2022/05/11(水) 19:46:57
>>2970
I don't think so.
They are easygoing.+3
-7
-
3002. 匿名 2022/05/11(水) 19:47:29
外で十分距離が取れればマスク外して良いとか、今に始まった話ではないと思うんですが。もともとは距離が取れていてもマスク必要だったってこと?+9
-0
-
3003. 匿名 2022/05/11(水) 19:47:35
>>2998
横だけど、渋谷の駅付近、代々木、原宿は普通に見かける
それこそ代々木上原は公園が近いからか特に多め+2
-0
-
3004. 匿名 2022/05/11(水) 19:47:42
>>2996
?どういうこと?+0
-1
-
3005. 匿名 2022/05/11(水) 19:48:05
>>2992
てか同じ会議に出てて、感染源はこの人!ってどうやって特定するの?
たまたま一番最初に発症した人?+6
-0
-
3006. 匿名 2022/05/11(水) 19:48:05
え〜けどそしたら男の人の顔半分鼻とか唇見れるのか〜ちょっと楽しいかも〜
なんか自分でも何言ってんだって感じだけど+0
-3
-
3007. 匿名 2022/05/11(水) 19:48:24
>>3000
免疫下がるし、獲得もできないから長い目で見てよくないんだよ。感染リスクが多少下がる根拠は?+7
-3
-
3008. 匿名 2022/05/11(水) 19:48:51
>>2833
横だけどこの前アルコール消毒液をなめて意識不明で救急搬送された子供いたよね。子供なんて普通に指なめたり顔触ったりするし。最近の幼稚園て園児にも消毒させてんのかな?コロナよりそっちのが怖い+3
-2
-
3009. 匿名 2022/05/11(水) 19:49:30
5年後も日本人はずっとつけ続ける人が大半でしょ+4
-4
-
3010. 匿名 2022/05/11(水) 19:49:36
日本人は事なかれ主義でマスクしておいたら何も言われないだろうという人ばかりだから
みんなで外そうとか付けても付けなくてもどっちでもいいよとはならない気がする。+4
-0
-
3011. 匿名 2022/05/11(水) 19:50:08
>>3001
横。イージーゴーイングなぐらいのほうがいいんだけど。インフルよりしょぼいとわかったのに深刻に捉えていたらコロナは大丈夫でも別の病気に罹るよ。+7
-0
-
3012. 匿名 2022/05/11(水) 19:50:40
>>2415
じゃあ半分とかいう根拠のない数値を出すべきじゃない+0
-2
-
3013. 匿名 2022/05/11(水) 19:50:49
>>3003
普通にってどの程度?
通勤で渋谷駅通るから今日意識してみたけど、子供と外国人を除いてノーマスクは居なかった。上原もたまに行くけど、ランナーでさえマスクしてたよ。
+4
-3
-
3014. 匿名 2022/05/11(水) 19:51:24
ここにいる人達はマスクなんて意味ないからしない、子どもはコロナに感染して抗体つけたほうがいいって人が多いのかな?
私のまわりは皆んな子どもがコロナに感染したらやっぱ心配だし気をつけている人の方が多いけど。
ガルちゃんと世の中のだと温度差すごいなぁ。+7
-1
-
3015. 匿名 2022/05/11(水) 19:51:52
>>3004
ずっとマスク付けて会議に出てて、その人が1人だけが発症して周りにいた人は感染しなかったのならマスクに他人に感染させない効果があるかも?って言えるけど
マスク付けてさえいれば周りに感染させなかったって証明はできないねってことだよ+3
-1
-
3016. 匿名 2022/05/11(水) 19:52:52
>>3007
安全性が高くて子どもにも使える薬が出てくるまで、できるなら罹りたくないよねぇ
感染したらその時はしょうがないけど、好き好んで罹りたい人なんているの?
コロナに限らず風邪でも嫌だよ+2
-3
-
3017. 匿名 2022/05/11(水) 19:53:04
>>3014
風邪でもインフルでも心配だけどマスク常時させるほどではない+3
-1
-
3018. 匿名 2022/05/11(水) 19:53:14
>>3009
いや、ノーマスクの外国人がきたら一気にしなくなるよ。+1
-3
-
3019. 匿名 2022/05/11(水) 19:53:49
>>3016
風邪にも薬ないんだから体調おかしいかな?と感じたら葛根湯でも飲んでて+7
-0
-
3020. 匿名 2022/05/11(水) 19:54:17
>>3016
風邪は健康な人にはいいのよ。大病予防になるから。そして小さい子には免疫獲得に必要なのよ。ググってきて。+8
-0
-
3021. 匿名 2022/05/11(水) 19:54:19
>>3015
感染源の人とその他数名はマスクつけたり外したりしていたよ
1人だけ罹らず済んだ人はお茶も飲まずにマスクつけっぱなしだった+3
-6
-
3022. 匿名 2022/05/11(水) 19:54:35
>>3019
自己免疫上げるしかないのよね。納豆とか乳酸菌も良いよ。+6
-0
-
3023. 匿名 2022/05/11(水) 19:54:45
>>3018
それはない+0
-0
-
3024. 匿名 2022/05/11(水) 19:54:48
子供にとってはRSウイルスの方が怖くない?
必死でマスク消毒してたんかって話+1
-0
-
3025. 匿名 2022/05/11(水) 19:55:13
飲食の厨房は暑いからってマスク外しても許されるのに介護施設の入浴介助は許されないんだね...冷房無しでサウナ状態なのに。+5
-0
-
3026. 匿名 2022/05/11(水) 19:55:24
一年中、花粉やらの鼻炎で鼻水やばいから
マスクつけ続ける😭
子供も花粉症酷くて外遊びの時もつけてるけど
さすがに暑くなってきたし
花粉よりも熱中症がこわいかな。+0
-0
-
3027. 匿名 2022/05/11(水) 19:55:28
>>3020
ここの人たちが風邪=コロナって極端に言ってくるから、それは違うよねって事が言いたいよ
コロナは分かってない事も沢山あるよね?後遺症出てる人もいるよね+1
-4
-
3028. 匿名 2022/05/11(水) 19:55:33
>>3016
感染リスクが多少下がる根拠を聞いてるんだけど。+1
-0
-
3029. 匿名 2022/05/11(水) 19:55:35
大阪府民です。
吉村知事からも屋外で人との距離がとれるとこならマスクなしとのお言葉頂きましたーやった〜
ありがとうAMS!!+1
-2
-
3030. 匿名 2022/05/11(水) 19:55:42
>>3020
たまに高熱出すのもいいって聞いた+3
-0
-
3031. 匿名 2022/05/11(水) 19:55:43
The society that everyone does not mask is shining✨![「屋外ではマスクをはずす」 東京都医師会が提案 段階的な感染対策解除も求める]()
+2
-1
-
3032. 匿名 2022/05/11(水) 19:56:15
>>3027
後遺症はどんな病気でもあります。あなたインフルエンザ脳症という言葉を聞いたことがないの?+4
-0
-
3033. 匿名 2022/05/11(水) 19:56:25
>>169
怖すぎる…+14
-4
-
3034. 匿名 2022/05/11(水) 19:56:26
>>3029
アモスよその距離ってどんくらいよ
5cmくらいでもいいのかな+1
-0
-
3035. 匿名 2022/05/11(水) 19:56:52
>>2654
仕事で都内と地方行き来してるけど、都内は繁華街でもちょいちょい見掛ける。地方はまあ皆まじめだよね。それでも広い公園では外す人増えてきた。+1
-0
-
3036. 匿名 2022/05/11(水) 19:57:35
>>3012
何の根拠もないのにマスクは意味ないって言い切るのはいいの?矛盾してない?+3
-7
-
3037. 匿名 2022/05/11(水) 19:57:41
>>3029
てか居酒屋さんやレストランでは誰もしてないんやけどな+5
-1
-
3038. 匿名 2022/05/11(水) 19:57:57
>>2799
無茶苦茶な基準だなw
調理のおばさんや食品工場はそこの企業内ルールに従えばいい。
あなたの基準は関係ない。押し付けがましいよ+2
-3
-
3039. 匿名 2022/05/11(水) 19:57:59
マスク義務解除されてもマスクを外さないといわれてた韓国
めちゃマスク外しだしてるじゃんw
[4K] Seoul Vlog - Hongdae Club & fashion street saturday night - 2022 South Korea Vlog Travel - YouTubeyoutu.beSeoul walker 4K Travel Vlog292 : Seoul VlogSouth KOREA Travel Tour 4K UHD【----Thank you so much for membership support.----]https://www.youtube.com/channel/U...">
+3
-2
-
3040. 匿名 2022/05/11(水) 19:58:16
>>3035
ほんそれ
地方の方が怖がってる印象+0
-0
-
3041. 匿名 2022/05/11(水) 19:58:39
>>2958
そういう配慮がないやつは基本口も臭いからマスクしといて欲しいわ。+1
-3
-
3042. 匿名 2022/05/11(水) 19:58:46
>>3005
そうそう。感染源の人の家族がコロナ感染してたって発覚して、本人にもうつってた。
で、会議に参加してた人が次々熱でたり咳が止まらなかったり。1人は症状無かったけど念のため検査したら陽性ってかんじ。+2
-0
-
3043. 匿名 2022/05/11(水) 19:58:50
>>3034
最後には個人の判断って言ってたから、あなたが5センチで距離がとれてると思ったら、それでいいかもよ!
私は30センチにしとく〜+0
-1
-
3044. 匿名 2022/05/11(水) 19:59:01
>>2999
コロナ前のインフルエンザで国は特にマスク推奨してないし、学校もマスクには何も触れてなかったでしょ
関係ないじゃん+1
-2
-
3045. 匿名 2022/05/11(水) 19:59:17
>>2940
肌荒れするから外したい
マスクしてると美意識も低下するし+1
-3
-
3046. 匿名 2022/05/11(水) 19:59:32
マスク厨なんて普通じゃないし変人しかいない+6
-5
-
3047. 匿名 2022/05/11(水) 19:59:34
>>3043
そうなんや
ありがとう
ほんなら私は1mmにしとこ+3
-0
-
3048. 匿名 2022/05/11(水) 19:59:48
>>3032
もちろん、聞いたことあるよ。毎年ワクチンを打ってるよ。+0
-0
-
3049. 匿名 2022/05/11(水) 20:00:36
>>2933
取れないしすでに死なせてる男児に対しても因果関係なしで終わらせてる+5
-0
-
3050. 匿名 2022/05/11(水) 20:00:37
万が一自分がコロナ、それを人にうつしてたら怖いからやっぱマスクはするなぁ
人気がないところなら外すかもだけど+1
-2
-
3051. 匿名 2022/05/11(水) 20:00:39
>>3021
もしかしてPCR信じちゃってる人?+10
-4
-
3052. 匿名 2022/05/11(水) 20:00:52
>>3036
根拠はあるよ。数秒で菌やウイルスの温床になるから。それを触るわけだよ。そして感染者は減らないじゃんか。下手したらマスクが感染源になってることも考えられるんだけどね。マスクは正面からの飛沫を防ぐことしかできないよ。
そして、遡ったらだれか書いてくれてるじゃん。いまだにコロナが治まっていないんだよ。マスクの意味ある?+7
-4
-
3053. 匿名 2022/05/11(水) 20:01:33
>>3046
逆だと思うけどw+4
-1
-
3054. 匿名 2022/05/11(水) 20:01:48
えっ、もう外では外してますが…+7
-1
-
3055. 匿名 2022/05/11(水) 20:01:58
>>3048
だったらコロナもワクチン打っておけばいいじゃんか。+1
-0
-
3056. 匿名 2022/05/11(水) 20:02:01
野外だろうと人が多いとこはして欲しい+8
-13
-
3057. 匿名 2022/05/11(水) 20:02:18
ノーマスクに対して嫌がらせをしてくる変人には刑罰を与えるべき+12
-2
-
3058. 匿名 2022/05/11(水) 20:02:23
>>3056
任意なのでしません。+5
-4
-
3059. 匿名 2022/05/11(水) 20:02:55
言われなくても人口密度の薄い場所ではマスクずらしてるよね+5
-0
-
3060. 匿名 2022/05/11(水) 20:03:00
>>3057
すでに訴えたらなにかしら成立するでしょ。遠慮なく通報してやる。+6
-0
-
3061. 匿名 2022/05/11(水) 20:03:17
マスクをしてない国々のが感染者少ないんだから、密集だろうが室内だろうがマスクをしない方が合理的なんだけどね+8
-3
-
3062. 匿名 2022/05/11(水) 20:03:22
保育士してるけど、ほんとにあっという間にコロナ広がったよ。対応が本当に大変だった。
マスクできないちっちゃい子だからしょうがないけど、やっぱり罹らないに越したことないと思ったよ。家庭内感染にもなって親御さんたち本当に大変そうだった。+5
-3
-
3063. 匿名 2022/05/11(水) 20:03:43
>>3054
だよね
通勤中真冬は寒いから着けることもあるけど基本外ではしたことないわ
コロナ初期はマスクしてない同士ニコッとすることもあったが最近はマスクなしも増えてるから平常通りの日々+6
-1
-
3064. 匿名 2022/05/11(水) 20:04:00
>>3061
そうそう。意味ないどころかかえって感染リスクをあげてどうするんだよね。+2
-3
-
3065. 匿名 2022/05/11(水) 20:04:01
コロナ禍で飛沫を可視化した映像を見過ぎて、もうマスクなしで生活できない…
会社でマスクを外せっていう圧をかけられないか心配。+4
-5
-
3066. 匿名 2022/05/11(水) 20:04:05
>>3062
検査するからでは...+5
-1
-
3067. 匿名 2022/05/11(水) 20:04:17
>>3055
一歳だから打てないし、コロナワクチンに関しては今の段階では子どもに打たせたくないなぁ
よくわからないワクチンだもの
私は打ったけどね+1
-2
-
3068. 匿名 2022/05/11(水) 20:04:44
感染症専門内科医 岩田健太郎 2018年発言
2009年新型インフルパニックのとき、阪急電車で全員がマスクしてたんです。
僕だけマスクつけていなくて「なんて非常識なんだろう」ってにらまれて「僕だけ正しいことしてるんだけどなあ」って思った記憶があるんです。
マスク、たいして意味ないんです。
一般的なマスクって鼻のところに隙間があってうつるときはうつるんですよ。
完全にブロックする効果はないです。
感染症専門内科医 岩田健太郎 2020.07.20発言
感染を起こしていない人がマスクをするのは無意味です。なぜかというと、飛沫というものは飛び散った後、周りの空間にウワウワと漂っているんですね。
だからマスクを着けても、じつは鼻の横やほっぺたの横、顎の下などが隙間だらけなので、飛んでいる飛沫なんてすぐに入ってきてしまうんです。なので、
症状のない人が飛沫に対してマスクを着けるのは、全くの無意味です。
マスクには、ウイルスから防御する能力はありません。マスクを作っている会社は「ここの層でウイルスをストップできますよ」みたいに性能を謳っていますが、
問題は布の性質ではなくて、隙間があるかないかなんです。+6
-4
-
3069. 匿名 2022/05/11(水) 20:04:52
>>3062
5類に下げればよい。風邪をひかせて家庭内感染で大変なのはずっと前からだよ。+10
-0
-
3070. 匿名 2022/05/11(水) 20:05:12
>>3066
いやいや、クラスターになったら大変だからね検査するよ
そんな適当な保育施設に預けたくないでしょ+1
-6
-
3071. 匿名 2022/05/11(水) 20:05:24
>>3068
ガスマスクしかないじゃんね。+3
-0
-
3072. 匿名 2022/05/11(水) 20:05:28
>>3027
風邪のウイルスの一種であることには間違いない+3
-0
-
3073. 匿名 2022/05/11(水) 20:05:29
>>3068
マスクが効果ないどころか
オミクロンだとむしろマスクが感染を拡大させてると思われる+2
-2
-
3074. 匿名 2022/05/11(水) 20:05:45
>>236
走ってるんだから息上がって当然でしょうよ。+2
-0
-
3075. 匿名 2022/05/11(水) 20:05:54
>>3065
かけられないから安心して。+2
-0
-
3076. 匿名 2022/05/11(水) 20:06:03
>>3061
そういう国はそもそも検査数が減ってるような+2
-1
-
3077. 匿名 2022/05/11(水) 20:06:07
>>3071
もしくはペストマスクでも可。+0
-0
-
3078. 匿名 2022/05/11(水) 20:06:11
>>3052
マスク意味ないですよね+6
-2
-
3079. 匿名 2022/05/11(水) 20:06:18
>>3058
しなければいいとおもう
変な人という目で見られるだけだから+4
-3
-
3080. 匿名 2022/05/11(水) 20:06:28
>>3067
インフルは打ったのに?+2
-0
-
3081. 匿名 2022/05/11(水) 20:06:32
>>3075
ワクチン接種もやらかしてたからやるとこあるかもしれんよ+0
-0
-
3082. 匿名 2022/05/11(水) 20:06:53
そもそも60代以下でオミクロンで死ぬ人なんて稀なのに、気にする必要あるの+5
-0
-
3083. 匿名 2022/05/11(水) 20:06:54
>>3070
小児科でも風邪っぽくても検査しなくていいよーのところもあるけどね
検査の精度どうなの?って感じだし
ジュースでも陽性なるしなぁ+3
-1
-
3084. 匿名 2022/05/11(水) 20:06:54
>>3076
検査しなきゃ減る病気ならそれ程度ってことじゃん!
+2
-2
-
3085. 匿名 2022/05/11(水) 20:07:08
>>3041
まじでそれ。このご時世人がいる空間でノーマスクでベラベラ喋ってるやつって見た目がアレなやつばっかり。むしろその顔隠しとけって思う。+4
-1
-
3086. 匿名 2022/05/11(水) 20:07:30
ここでマスクなんてしないよ?って言ってる人ってリアルの世界でもしてないの?
たまに人混みでもマスクしてないヤバイ人いるけど、ガルちゃん民なのかな?+4
-11
-
3087. 匿名 2022/05/11(水) 20:07:35
>>3079
余計なお世話だわ。変な目で見られても別にいいです。屋外ぐらい外します。+11
-2
-
3088. 匿名 2022/05/11(水) 20:07:41
>>3079
最近はマスク信仰してる人の方が、変な人と見られてるよ+11
-4
-
3089. 匿名 2022/05/11(水) 20:07:56
>>3070
病気が大変というよりシステムが大変なのでは?ということでは?+0
-0
-
3090. 匿名 2022/05/11(水) 20:07:58
>>3070
クラスターになったらどうたいへんなのよ
そもそも検査しなけりゃクラスターにもならないんだよ+7
-1
-
3091. 匿名 2022/05/11(水) 20:08:04
>>1927
ほんとそう!
こう言う人がいる限りコロナは終わらない+10
-3
-
3092. 匿名 2022/05/11(水) 20:08:11
>>3080
不活化ワクチンだからね+1
-0
-
3093. 匿名 2022/05/11(水) 20:08:37
>>3082
ないよ。薬もワクチンもなくても余裕だわ。年取ったら気をつけないといけないけど、それで死ねるならそっちのほうがいい。認知症や癌のほうが嫌だよ。+4
-0
-
3094. 匿名 2022/05/11(水) 20:08:39
>>3089
全ての元凶2類相当+7
-0
-
3095. 匿名 2022/05/11(水) 20:08:43
>>2802
マスクしててもウイルスはだだ漏れで飛沫は飛ばないかもしれないけど、コロナは空気感染もするしなぁ。それよりお年寄りや子供は呼吸が弱いし、熱中症とかのが心配。外す人が多くなればそんな空気になっていくから、その第一歩としてしてない人もありだと思ってる。+4
-0
-
3096. 匿名 2022/05/11(水) 20:08:45
>>3079
マスク信者は一言余計なんよ
その負け惜しみみたいな嫌味言わないと気が済まないの?
マスクしっぱなしだからイライラしてんのかな+5
-2
-
3097. 匿名 2022/05/11(水) 20:09:00
韓国でさえマスク外しだしたのに、落ちぶれたよね日本人って
日本人の頭のいい人はみんなマスク批判してるのに
頭の悪い人やキチガイクレーマーにあわせすぎだよ
+9
-1
-
3098. 匿名 2022/05/11(水) 20:09:07
>>3087
どうぞお好きに
人と話す時はつけてた方がいいよ+0
-6
-
3099. 匿名 2022/05/11(水) 20:09:24
マスクの四方に両面テープ貼ってみな
マスクなんてコロナ意識してるのパフォーマンス+1
-0
-
3100. 匿名 2022/05/11(水) 20:09:27
>>2982
そうそう。なぜか0か100かでしかコメントしないよね。
マスクの感染予防効果も0か100かしかないみたい。笑える。+2
-1
-
3101. 匿名 2022/05/11(水) 20:09:43
>>3086
してないよ
マスクしてないだけでヤバい人だとレッテル貼りするあなたは正にいじめっ子だね
性格の悪さはコロナ前から?+18
-2
-
3102. 匿名 2022/05/11(水) 20:09:48
エビデンスもない、現実の結果が出てないのに、マスクをする理由はどこにあるのか
+11
-0
-
3103. 匿名 2022/05/11(水) 20:10:04
>>2854
電車でもマスクしてない
え、飲食店ではマスク外して食事してるけどどう違うの+6
-0
-
3104. 匿名 2022/05/11(水) 20:10:52
>>3098
いちいちうるさい。本当余計なお世話。ソーシャルディスタンスをとって外します。あなたと話すことなんてないだろうから余計な心配だわ。+8
-1
-
3105. 匿名 2022/05/11(水) 20:11:04
>>43
顎マスクきたなっ+1
-5
-
3106. 匿名 2022/05/11(水) 20:11:04
>>3086
してないー苦しいもん
自由に呼吸させて
お店ではするときもある+8
-0
-
3107. 匿名 2022/05/11(水) 20:11:11
このトピでマスク信者の性根の悪さを知った+14
-1
-
3108. 匿名 2022/05/11(水) 20:11:22
でも 都市と田舎一律で同じはおかしい+0
-3
-
3109. 匿名 2022/05/11(水) 20:11:23
マスク外したいって言ってる人は黙って外せばいいじゃんね
何ムキになってマスクしたいって言ってる人叩いてるんだろ
外すのが自由なら付けるのも自由じゃんね
コロナに罹りたくないからマスクするって言ってんのに、コロナを恐れるな!とか罹ってコロナの抗体つけろ!とかめちゃくちゃすぎるw+6
-8
-
3110. 匿名 2022/05/11(水) 20:11:58
>>3081
辞めればいいよ。+0
-0
-
3111. 匿名 2022/05/11(水) 20:12:01
>>3098
ずっとマスクつけててね
今年の夏も来年もずっと
コロナは無くならないから
私はマスクすでにつけてないけど+7
-2
-
3112. 匿名 2022/05/11(水) 20:12:03
>>2855
丸の内線の向かいの席の人も外してたよ+3
-1
-
3113. 匿名 2022/05/11(水) 20:12:13
間違いなくいえるのは知能レベルの低い人ほど、マスクマスクいってる
+12
-1
-
3114. 匿名 2022/05/11(水) 20:12:22
>>3104
私の周りにはあなたみたいな人いなくて良かった
+1
-5
-
3115. 匿名 2022/05/11(水) 20:12:37
>>2880
あなたが決める事じゃないんでね+2
-0
-
3116. 匿名 2022/05/11(水) 20:12:49
>>3109
しろ、という圧をかけておいてそれはないわ。
そんなこと言うなら、あなたはなにがなんでも外さないでね。+12
-0
-
3117. 匿名 2022/05/11(水) 20:12:56
>>3111
TPOに合わせてつけたり外したりするよ
+0
-1
-
3118. 匿名 2022/05/11(水) 20:13:12
>>3113
だって、理屈がわかってないもんね。+8
-0
-
3119. 匿名 2022/05/11(水) 20:13:19
![「屋外ではマスクをはずす」 東京都医師会が提案 段階的な感染対策解除も求める]()
+5
-0
-
3120. 匿名 2022/05/11(水) 20:13:21
>>3114
押し付けがましいマスク信仰まじ怖い+9
-1
-
3121. 匿名 2022/05/11(水) 20:13:40
今、感染者増加中。
ワクチン未接種や効果が薄れやすい高齢者で重症者が増えて、救急医療が機能ストップしだしたらどうするんだろう。自分に都合がいい解釈をする人も多いので、医療逼迫しそうになった場合はマスクに戻ると言う文言を添えて欲しい。
この人は医者だけど、イベルメクチン推したり。感染症の専門家の助言が欲しい。
BA2.12.1だったかな。日本にも2ヶ月後には流行る可能性があります。国外では、名前はオミクロンでも、デルタの要素が入る物が既に出ています。これはワクチン未接種者だと若くても重症化する人が増えそうです。
オンとオフを大事に、普段の生活を取り戻しつつも、感染対策はしっかりしたい。もう、完全な自粛は勘弁です。
+1
-6
-
3122. 匿名 2022/05/11(水) 20:13:54
>>3116
圧なんてかけてないよ。個人の自由だと思うからね。
私はその都度その環境に合わせてマスクするし、野外で人がいないなら外すよ。+0
-4
-
3123. 匿名 2022/05/11(水) 20:13:58
>>3114
私こそそれ言いたいんだけど。ほんと知り合いじゃなくてよかったわ。
+6
-0
-
3124. 匿名 2022/05/11(水) 20:14:06
>>3117
え!?外してんの!?
じゃあ他人にとやかくいうなよ(笑)
+7
-0
-
3125. 匿名 2022/05/11(水) 20:14:14
>>2865
岩城滉一発見!+1
-0
-
3126. 匿名 2022/05/11(水) 20:14:30
>>3021
だから、それで言えるのはマスク付けてさえいれば感染しないかも?ってことだけで、マスク付けてさえいたら他人に感染させないことの証明は出来ないよねってことだよ
会議に出てた5人のうちにウイルス保有者が1人混じっていたとして、その保有者がずっとマスク外さずにいて同じ会議に出てた他の4人に感染しなかったっていうならマスクに他人に感染させない効果があるかも?って言える+8
-2
-
3127. 匿名 2022/05/11(水) 20:14:34
>>3123
あなたおもしろいね!毎回返事してくれる!+0
-4
-
3128. 匿名 2022/05/11(水) 20:14:38
>>1
感染者が増えるだけ+0
-2
-
3129. 匿名 2022/05/11(水) 20:14:43
>>12
マイナス多いけど現状はそうだよね。一定の距離が取れる屋外では外してもいいよって話だってTVで言ってたし+12
-2
-
3130. 匿名 2022/05/11(水) 20:15:11
>>125
それなんていうの?その商品教えて下さい🙇♀
それ沢山買って経済回します。+0
-0
-
3131. 匿名 2022/05/11(水) 20:15:39
>>3109
だからマスクつけてもコロナに罹るんだって
なんでまだ分かんないのかな
勉強苦手な人?+7
-0
-
3132. 匿名 2022/05/11(水) 20:15:43
>>3052
結局それも憶測でしかないよね?
感染者が全員ノーマスクでくしゃみや咳をしてそこらへんに飛沫を飛ばしまくったのと比較出来ないから何ともいえないわ。+2
-2
-
3133. 匿名 2022/05/11(水) 20:15:43
>>2745
富岳の研究結果見てないの?+0
-0
-
3134. 匿名 2022/05/11(水) 20:15:52
>>3098
接客業してますがこの気持ちは当たり前。こっちもかかってるかもしれないからする。お客さんもそうしてほしい。だから室内ではしましょう、ってやつなのに
私はだいぢょおぶだしいーのぉレベルのやつがいる。こまったもんだわ+4
-7
-
3135. 匿名 2022/05/11(水) 20:16:18
マスクはずっとするつもり
顔を隠せるって色々なメリットがある+1
-6
-
3136. 匿名 2022/05/11(水) 20:16:38
>>3129
テレビで笑+1
-1
-
3137. 匿名 2022/05/11(水) 20:16:45
>>3122
私も初めからずっと外ではつけていないけど、世の中の人は圧をかけあってきたでしょ。自分がそうじゃないからってそれはない。もう屋内でも外したいんだわ。
それにコロナの抗体ができることはいいことじゃんか。何が悪いのよ。+9
-1
-
3138. 匿名 2022/05/11(水) 20:16:48
>>12
店名を教えろ+1
-4
-
3139. 匿名 2022/05/11(水) 20:16:57
医師会が出る幕じゃねえ〜
個人の判断
常識を持って自分で考える
それができれば医師会と政府が舵を
取るよりは確実にマシなもんが仕上がる+3
-2
-
3140. 匿名 2022/05/11(水) 20:17:10
>>1280
本当ですね汗
マスク外さないですみます
一安心です+0
-1
-
3141. 匿名 2022/05/11(水) 20:17:19
>>3121
この事はあんまり知らないから教えて欲しいんだけど(ニュースなんてそっちのけで学生生活満喫していた)
新型インフルエンザで千万人も感染者が出ていた時はどうなっていたの?逼迫していたの?+1
-2
-
3142. 匿名 2022/05/11(水) 20:17:41
>>3109
コロナに罹って治して抗体作るのが一番いいのは確かだよ
それが普通なんだよ+2
-1
-
3143. 匿名 2022/05/11(水) 20:17:45
WHOももうやる気ないよね
感染力強くなりすぎてどうやったって抑え込みは無理
治療法もワクチンもあるから適当に付き合っていけば?って感じ
御主人様の中国に苦言を呈してるくらいだもの
本当に無理なのだろう
無理なのにこのマスクはいつまでするのだろう?
ゴールないよ?
+1
-0
-
3144. 匿名 2022/05/11(水) 20:18:06
>>3128
根拠は?+0
-0
-
3145. 匿名 2022/05/11(水) 20:18:38
皆が外すなら外す。皆が外さないなら外さない+0
-1
-
3146. 匿名 2022/05/11(水) 20:18:46
子供連れて公園行ったら本当に苦しくて死にそうなるから鼻だけでも出させてくれたら助かる+2
-0
-
3147. 匿名 2022/05/11(水) 20:19:00
>>3135
勝手にどうぞ
マスクしない人の事をとやかく言わないで+5
-0
-
3148. 匿名 2022/05/11(水) 20:19:24
>>3086
屋内施設や電車・店内ではマナーとしてマスクするけど外を歩いてる時は基本してない。この季節息苦しくてもう無理だよ。
ついこの間、人通りのない住宅街をマスクなしで歩いてたら道路の反対側を歩いていたおっさんに「マスクちゃんとつけましょーねー!!!」って大声で言われてマジでびっくりした。マスク警察ってほんとにいるんだなって。+8
-1
-
3149. 匿名 2022/05/11(水) 20:19:29
>>3127
+0
-0
-
3150. 匿名 2022/05/11(水) 20:19:30
>>1
もうマスクしてない
屋内もずっとノーマスク
律儀に医師会の言いなりになってる人は馬鹿ですね+1
-0
-
3151. 匿名 2022/05/11(水) 20:19:41
>>3103
満員電車だと他人と距離が近い。+3
-4
-
3152. 匿名 2022/05/11(水) 20:19:43
>>3
ナイスパ!
みんなはずそう!+5
-1
-
3153. 匿名 2022/05/11(水) 20:19:49
>>18
がっかりされなくて済むから早く外したい+7
-0
-
3154. 匿名 2022/05/11(水) 20:20:00
>>3101
すごい極端すぎてわらっちゃったw
会話が通じないw
その一言多いところとかもやっぱ変
+3
-6
-
3155. 匿名 2022/05/11(水) 20:20:04
マスク内は雑菌繁殖したり口呼吸により免疫下がりだしたり余計に色んなウィルスに負けやすい体になると思うしこれからは暑くなり熱中症や低酸素も危険
デメリットの方が多すぎると思う
くしゃみや咳するときは服やハンカチでキャッチで周りへの配慮ぐらいでいいかと
これから梅雨でどんよりマスクで気分もどんより
鬱に繋がりそう
+7
-0
-
3156. 匿名 2022/05/11(水) 20:20:05
100年前に起きたパンデミック、スペイン風邪で大量死した死因はワクチンの過剰摂取とマスクによる細菌性肺炎でウイルスではなかった
人口削減として確信的にやってるよね![「屋外ではマスクをはずす」 東京都医師会が提案 段階的な感染対策解除も求める]()
+12
-4
-
3157. 匿名 2022/05/11(水) 20:20:09
>>2998
特定しようとしてきて怖い+3
-3
-
3158. 匿名 2022/05/11(水) 20:20:39
>>3148
あんたこそ、飛沫飛ばすなよ、と思うよね。+6
-0
-
3159. 匿名 2022/05/11(水) 20:21:12
>>3154
ブーメランすぎて。+3
-0
-
3160. 匿名 2022/05/11(水) 20:21:31
>>2907
やっと気づき出したか+1
-0
-
3161. 匿名 2022/05/11(水) 20:21:46
>>3113
そもそも年寄りとバカしかいないよね。未だコロナ怖い人。+4
-2
-
3162. 匿名 2022/05/11(水) 20:21:56
>>3137
じゃあ外したらいいよ
そんなにコロナの抗体つけたいなら罹ればいいじゃん+3
-0
-
3163. 匿名 2022/05/11(水) 20:22:06
>>61
飲食店の厨房も辛いTT
激暑TT苦しいTT+8
-0
-
3164. 匿名 2022/05/11(水) 20:22:17
>>3133
富嶽はなんのデータをもとに計算してるの?+0
-2
-
3165. 匿名 2022/05/11(水) 20:22:41
うちは持病がある人がいるからマスクはやっぱ怖くて外せないなぁ+1
-0
-
3166. 匿名 2022/05/11(水) 20:23:00
>>3109
黙って外してるよ
外してるってコメントしたら嘘だー!どこらへんの話ー?マスク外してる人ってヤバい人しかいないよねーって悪口で圧かけてるのはマスク信者の方なんだけど+5
-2
-
3167. 匿名 2022/05/11(水) 20:23:02
>>3164
横だけど、小麦粉くしゃみのほうが信頼性あるよ。+1
-0
-
3168. 匿名 2022/05/11(水) 20:23:02
外したい人だけ外せば?
マスクが他人に害を与えることはないんだから人に押し付けることではない。へんなの+6
-2
-
3169. 匿名 2022/05/11(水) 20:23:21
マスク生活で明らかにインフルの数減ったし 子供も体調崩さなくなった
でもこれから暑いから子供はマスク外せるほうがいい+3
-2
-
3170. 匿名 2022/05/11(水) 20:24:08
リアルでマスクしてない人を見かけないけど、ここの人達どこに住んでるんだろ+6
-0
-
3171. 匿名 2022/05/11(水) 20:24:34
>>3168
つけるようになったのが変なんだよ。いまさら何言ってるの?+1
-3
-
3172. 匿名 2022/05/11(水) 20:24:43
>>3148
ここにもイカれたマスク警察ババアが沢山いるよ+5
-0
-
3173. 匿名 2022/05/11(水) 20:25:00
>>147
忘れた人に限って、忘れちゃったよーアハハ!って話しかけてくるの。バカなのかな。コンビニなんだから、黙って買えや!+2
-1
-
3174. 匿名 2022/05/11(水) 20:25:03
今ってスーパーとか薬局とかコンビニもマスクしてないと入れないけど、ここの人たちは店入る時はマスクするの?+2
-1
-
3175. 匿名 2022/05/11(水) 20:25:24
>>3133
・小声で話した場合
・鼻マスクで話した場合
・常に風が吹いてると想定した屋外で話してる場合
・換気が行き届いてる密室で話した場合
もやって。
あと「屋内で換気してない狭い部屋で無症状が感染させる確率」もやって。
そもそも咳をする時って真下を向くか横を向いて腕に口を押し付けてやるでしょ?+2
-0
-
3176. 匿名 2022/05/11(水) 20:25:43
>>3456
気持ち悪い画像貼るなよ
それを培養してんじゃん+2
-0
-
3177. 匿名 2022/05/11(水) 20:25:45
>>3170
よく見てみなさいよ。外では増えてきてるから。同調圧力が強固なとこに住んでいたら知らないけどね。+0
-3
-
3178. 匿名 2022/05/11(水) 20:25:47
もう3年目だよ!外したいよ!!+2
-0
-
3179. 匿名 2022/05/11(水) 20:25:54
>>3168
ねー。ほんとへん。勝手に外せばいいのにね。+1
-1
-
3180. 匿名 2022/05/11(水) 20:26:06
>>3170
未開の地に住んでるの?+1
-2
-
3181. 匿名 2022/05/11(水) 20:26:59
>>3179
ずっと意味のないことを平気でやってる人たちに言われたくないわ。+2
-0
-
3182. 匿名 2022/05/11(水) 20:27:02
>>3177
私もマスク自体は鬱陶しいし外したいけど、周りにマスクしてない人なんて1人もいないんだよね。+3
-0
-
3183. 匿名 2022/05/11(水) 20:27:14
梅雨時期のマスク内の菌の繁殖やばそう
これからは心配な人だけマスク
風邪の人だけマスク配慮の方向でお願いしたい
今の時期は気温の高低差激しいからいきなり暑い時子供のマスクは危ない
年配の方もいつのまにか倒れそう+4
-0
-
3184. 匿名 2022/05/11(水) 20:27:19
>>3063
良かった、怒られるかと思った(笑)
自転車通学の息子にも、
外して行かせてます。
酸欠になったら困るので…
もちろん、他人がいる時には
直ぐにつけてます。+1
-0
-
3185. 匿名 2022/05/11(水) 20:27:33
>>3174
マスクしなくても普通に入れる+6
-0
-
3186. 匿名 2022/05/11(水) 20:27:33
>>3109
マスクしたいって言ってる人叩いてなんかないよ
したい人はずっと付けてていいんだし
マスク外したい人に外すな!って押し付けてる人が反論されてるだけだよ+6
-0
-
3187. 匿名 2022/05/11(水) 20:27:55
>>3153
どうせ外さなければいけない場合があるもんね。+1
-0
-
3188. 匿名 2022/05/11(水) 20:27:58
>>1026
髪長くすれば完全に私だわ+0
-0
-
3189. 匿名 2022/05/11(水) 20:28:08
>>3171
前からつけたい人はつけてたでしょ+0
-0
-
3190. 匿名 2022/05/11(水) 20:28:22
>>3181
実費でマスク買って着けるののなにが悪いんだろ
感染リスク少しでも下がるなら付けたいなー+0
-0
-
3191. 匿名 2022/05/11(水) 20:28:30
屋内でも密室じゃなければ付けなくてもよくない?+2
-0
-
3192. 匿名 2022/05/11(水) 20:28:35
>>2988
バカはそれがわからないのよ+1
-0
-
3193. 匿名 2022/05/11(水) 20:28:42
>>3182
あなたがその一人になればいいんじゃん。わたしは屋外ではコロナの初期から外してる。+0
-2
-
3194. 匿名 2022/05/11(水) 20:28:42
>>336
おパカなの?+0
-0
-
3195. 匿名 2022/05/11(水) 20:29:21
>>3193
や、それはいいや笑+3
-0
-
3196. 匿名 2022/05/11(水) 20:29:23
>>3191
もうね、密室でもつけなくていいと思うわ。どう考えたって意味ない。+0
-0
-
3197. 匿名 2022/05/11(水) 20:29:33
>>3061
さっさとマスクなんて外して菌を交換しあって
発症してしなくてもコロナにかかって集団免疫するのが手っ取り早いのに
日本がここまで非科学的で妄信的な国とは思わなかった。
先進的な欧米と真逆で、どんどん没落していくのもうなずける。+0
-0
-
3198. 匿名 2022/05/11(水) 20:29:51
>>3190
ほんとよ。メガネやめてコンタクトにしろって強制されてるようなもの。+0
-0
-
3199. 匿名 2022/05/11(水) 20:30:35
>>3147
別にとやかく言ってないけどw+0
-0
-
3200. 匿名 2022/05/11(水) 20:30:41
>>3186
あなたみたいな人も中にはいるんだけど、さっきから徹底的にマスクしてる奴は馬鹿、無駄、罹って抗体作れって言う人もいるのよー
+1
-0
-
3201. 匿名 2022/05/11(水) 20:31:05
>>3189
何すっとぼけたこと言ってんのよ。マスク着用の要請なんてアナウンスすらされてなかったわ。ほぼ全員がマスクしなきゃいけない状況から外すって大変なんだけど。あなたはずっとつけておいてね。+5
-2
-
3202. 匿名 2022/05/11(水) 20:31:05
>>3168
空気感染するのでエアロゾルにより感染リスクを高めますね
そもそもウイルスをマスクで防ごうなどザルで水をすくうようなもので良いことはないです![「屋外ではマスクをはずす」 東京都医師会が提案 段階的な感染対策解除も求める]()
+11
-7
-
3203. 匿名 2022/05/11(水) 20:31:15
>>3174
入れるよ。
お願いだから。
してない人もいるけど店員なんか誰も注意なんかしない。+10
-2
-
3204. 匿名 2022/05/11(水) 20:31:19
>>3049
くそ機関でごわすね+2
-0
-
3205. 匿名 2022/05/11(水) 20:31:19
>>3185
入れることは入れるけど、着用願いのアナウンスが苦痛すぎる
大手のアナウンスがうるさいとこは行かずに
ノーマスクでも寛容的な個人経営店に行くようになった+7
-4
-
3206. 匿名 2022/05/11(水) 20:32:59
>>3198
マスク着けてない人なんて周りにいないもんなぁ
みんなそれぞれ配慮しあってる
マスクつけたくない人はつけなくてもいいと思うけどね、自由だし+3
-4
-
3207. 匿名 2022/05/11(水) 20:33:06
>>1
世の中には飛沫感染する危険なウイルスがいっぱいいる
人がいる場所や涼しい屋内ではマスクはしたほうがいい
自分の身と大切な人を守るために
【専門家解説】『原因不明の子どもの肝炎』考えられるのは「アデノウイルス」や「コロナウイルス」が関係?国内の子どもの肝炎状況なども解説 | 特集 | MBSニュースwww.mbs.jp世界で報告が相次いでいる『原因不明の子どもの肝炎』。4月21日時点では、イギリスなど12の国で、16歳以下の子ども計169人について報告されていて、うち17人は肝移植が必要な重篤な状態になり、うち1人は死亡したという情報があります。そして4月25...
原因不明の急性肝炎 “これまでに348人の患者” WHO | NHKwww3.nhk.or.jp【NHK】欧米などで幼い子どもを中心に報告が相次いでいる原因不明の急性肝炎について、WHO=世界保健機関はこれまでに348人の患者…
原因不明の小児急性肝炎、国内で新たに4人 アデノウイルス検出も:朝日新聞デジタルwww.asahi.com海外で原因不明の子どもの急性肝炎の報告が相次いでいる問題で、厚生労働省は6日、可能性のある患者として国内で新たに4人の報告があった、と発表した。合計で7人となり、このうち1人から、英国などが関連性を…
謎の小児肝炎、アデノウイルスが原因の可能性 - BBCニュースwww.bbc.com医療当局者によると、幼い子供を中心に広がっている珍しい肝炎と、一般的なアデノウイルスに関連がある証拠が次々と出てきている。
「感染経路 アデノウイルスは人から人へ感染します。感染力は大変強いです。咳や鼻水の飛沫で感染します。」+7
-3
-
3208. 匿名 2022/05/11(水) 20:33:08
これからも色んなウィルスは変化するし出てくるから免疫を上げるしかないな
ちゃんと寝て食べて無理せずたくさん笑って
コロナにより良かったことは無理はしなくていいという事が受け入れられ出したこと
高熱でドヤ顔で出勤する人もいなくなり周りも風邪の時に無理しなくていい
無駄な集まりももっとなくなりリモートやオンラインでもいいよという空気感はいい
換気しつつ暖房とかもインフル予防にも良かったと思う+10
-0
-
3209. 匿名 2022/05/11(水) 20:33:20
>>5
息臭いしに見えた…
疲れてるのかな+0
-0
-
3210. 匿名 2022/05/11(水) 20:33:34
>>2674
うん、ね。
みんななんで必死にマスクしてんの?!
って思ってました。(笑)(笑)+8
-3
-
3211. 匿名 2022/05/11(水) 20:33:52
>>3203
コンビニは行けそうだわ。やってみる。
今日は映画館で顎マスクだったよ。昼でめっちゃ空いていたし、映画館は換気システムが整ってるからね。そのうち外すわ。+7
-4
-
3212. 匿名 2022/05/11(水) 20:34:34
>>3206
マスクを信じても救われませんよ+5
-4
-
3213. 匿名 2022/05/11(水) 20:34:44
>>3208
そうそう。以前と違って休むようになったのはよかったよね。+2
-0
-
3214. 匿名 2022/05/11(水) 20:34:50
ここにいる人たちってマスク付けたい人のことボッコボコに叩いてて笑える
つけたり外したり時と場合でいいと思うのに、マスク付けるなら一生外すなよ!とかいって話通じない
ガルちゃんおもろ+7
-1
-
3215. 匿名 2022/05/11(水) 20:35:14
>>3212
や、信じるとか信じないとかじゃなくて、、+3
-0
-
3216. 匿名 2022/05/11(水) 20:35:19
>>1822
うん、ずっとそれを続けてればいいんじゃない?外す人は外す。それが嫌な人は屋外でも夏でもマスクしてれば良い。+3
-1
-
3217. 匿名 2022/05/11(水) 20:35:40
>>3207
いまさらだよ。ノロも怖いんだけど、それがマスクで防げるのか、という話だよ。+7
-1
-
3218. 匿名 2022/05/11(水) 20:36:10
毎日暑いよ
マスク外したい😣+5
-1
-
3219. 匿名 2022/05/11(水) 20:37:05
>>3212
予防の為に念のためのマスクなだけで、マスク命!これなきゃ死ぬ!とかではないと思うよ
もし自分がコロナに感染してて、周りにうつすのも嫌だしね+3
-0
-
3220. 匿名 2022/05/11(水) 20:37:15
>>3168
外してるよ
外してる人に対してヤバい人とか書くのやめなよってだけ+1
-2
-
3221. 匿名 2022/05/11(水) 20:37:38
>>3214
こうやってマウント取りたいだけなんだろうね。
+0
-4
-
3222. 匿名 2022/05/11(水) 20:37:46
>>3174
全部入れる
全く注意されたことない+5
-2
-
3223. 匿名 2022/05/11(水) 20:38:03
>>3206
マスクつけてない人が配慮してないって決めつけやめなよ
+3
-2
-
3224. 匿名 2022/05/11(水) 20:38:11
感染するのが嫌だから少しでもリスク抑えるためにマスク着けたいだけなのに、マスク信者呼ばわり笑える+7
-4
-
3225. 匿名 2022/05/11(水) 20:38:35
>>3207
マスクより重要なのは免疫力です
マスクは免疫力を低下させます
+13
-1
-
3226. 匿名 2022/05/11(水) 20:38:36
>>3214
マスク外したい人の事をボコボコに書いてるからお互い様では?+5
-2
-
3227. 匿名 2022/05/11(水) 20:38:50
>>3202
みんな外してるなかつけていたら危険だけど、みんなつけてたときは安全なものだった+2
-1
-
3228. 匿名 2022/05/11(水) 20:38:54
>>3224
少しでも下がるという根拠は?+1
-2
-
3229. 匿名 2022/05/11(水) 20:38:58
>>3224
リスク抑えられないって何度教えれば理解できるんだろう+2
-2
-
3230. 匿名 2022/05/11(水) 20:39:20
>>3223
もし自分がコロナに罹っていたらどうするの?
ノーマスクで会話してたら配慮していないと言うことになると思うけど、、+3
-6
-
3231. 匿名 2022/05/11(水) 20:39:23
>>3227
そうでもないでしょ。マスクがものすごく汚いのに。+3
-1
-
3232. 匿名 2022/05/11(水) 20:40:03
>>3226
外したいなら外せばいいんじゃない?って言ってんじゃんw+1
-2
-
3233. 匿名 2022/05/11(水) 20:40:34
>>3219
マスクをしてても飛沫が飛び散りますよ+1
-1
-
3234. 匿名 2022/05/11(水) 20:40:39
>>3226
どちらかというと、ガル民でいうなら、これまでマスクしていない人をボッコボコにしてきてるよね。+5
-1
-
3235. 匿名 2022/05/11(水) 20:41:11
>>5
リップも嬉しいけどメガネもかけられる!
いつも吐く息でメガネが曇っちゃうからメガネできなかった+5
-1
-
3236. 匿名 2022/05/11(水) 20:41:17
喉痛くて倦怠感ありなんだけど、コロナかなぁ…+0
-0
-
3237. 匿名 2022/05/11(水) 20:41:30
>>3229
リスク抑えられてるでしょw
少なからずコロナの検査してる医療従事者はマスクしてるよね+1
-3
-
3238. 匿名 2022/05/11(水) 20:41:41
>>10
その
「ダメ」はいつまでダメなのかな?
+0
-0
-
3239. 匿名 2022/05/11(水) 20:42:28
>>3222
ノーマスクの人いたけど、みんなからジロジロ見られてたなぁ+1
-0
-
3240. 匿名 2022/05/11(水) 20:42:29
>>30
よく行くラーメン屋のアクリル板にラーメンの汁が飛び散ってて気持ち悪い。
あれ見ると食欲なくすからしばらく行ってないわ、、+6
-0
-
3241. 匿名 2022/05/11(水) 20:42:40
>>248
マスクつけてる方が顔小さく見えない?人によるのかな+3
-0
-
3242. 匿名 2022/05/11(水) 20:43:19
>>3236
春はそうなりがち。胃が荒れてるかもよ。気になるなら病院へ。+0
-0
-
3243. 匿名 2022/05/11(水) 20:43:38
>>3239
だからなに?+3
-1
-
3244. 匿名 2022/05/11(水) 20:43:43
>>3036
飛沫感染といわれていたけど空気感染でした。
はい、マスク意味なし+3
-2
-
3245. 匿名 2022/05/11(水) 20:43:44
青春時代マスクで終わった層は
マスクなし生活になってもそのまましてそうだよね
外すのが怖い的な+1
-0
-
3246. 匿名 2022/05/11(水) 20:43:52
みんなマスク外したいのかー
私はマスク生活長すぎて今更外せないかな
最近マスクしてない人増えたけどやっぱり見かけたら嫌だなあと思ってしまう
リスク関係ないとかでも少しでも可能性は防ぎたいわ+4
-6
-
3247. 匿名 2022/05/11(水) 20:44:26
>>1455
やだよ他人のくしゃみや咳吸い込んだり顔に唾がピトッて飛んできたりするの気持ち悪いもん。+1
-0
-
3248. 匿名 2022/05/11(水) 20:44:30
なんでも強要しないことで平和が訪れそう
集まりに行く行かない
マスクするしない
PTAはりきりたいはりきりたくない
ワクチン打つ打たない
ガン治療に対する見解も信じたことを本人がした方が効くとか何とか
他人に強要されても本人が疑ってたら病になりそう
+0
-0
-
3249. 匿名 2022/05/11(水) 20:44:30
>>3243
世の中いろんな人がいるのに、すげーなってかんじ+1
-1
-
3250. 匿名 2022/05/11(水) 20:44:54
>>3237
院内感染対策です。対策が予防になっているのか、といえば必ずしもそうじゃないと思う。+2
-4
-
3251. 匿名 2022/05/11(水) 20:45:00
台湾での1日あたりの感染者数42,501件。日本の人口の1/6なので、日本でいったら25万人。
もちろんマスク国+5
-0
-
3252. 匿名 2022/05/11(水) 20:45:59
>>3237
病院はクラスターがよく発生しますよね+3
-0
-
3253. 匿名 2022/05/11(水) 20:46:01
>>3244
本当空気なら意味ないよ。しかも飛沫といっても正面だけだからね。左右上下ザルだよ。+3
-2
-
3254. 匿名 2022/05/11(水) 20:46:19
付けたい人は付ける自由もあるからね。+12
-0
-
3255. 匿名 2022/05/11(水) 20:46:30
私2年前からずっと屋外でも屋内でもマスクつけてませんよ。やっと時代が私に追いつきましたね+9
-11
-
3256. 匿名 2022/05/11(水) 20:47:31
>>3254
そうそう。そこはとやかく言わないわ。+1
-0
-
3257. 匿名 2022/05/11(水) 20:47:39
>>3249
羨ましいなら外せば?+3
-1
-
3258. 匿名 2022/05/11(水) 20:47:43
屋外でもたまにすれ違いざまにめっちゃ咳するジジイおるんよなー
あれまじイヤ
屋外でマスクはずしたいけど、ジジイのあれがあるから嫌+10
-0
-
3259. 匿名 2022/05/11(水) 20:48:31
>>3255
飛行機や新幹線でも何も言われなかったの?+4
-0
-
3260. 匿名 2022/05/11(水) 20:48:37
>>606
マスクランはコロナよりずっと危険だし致命的になる
気温25度、湿度90%なのに誰もいない道でマスクして走ってるおばさんがいて本当に心配になった
最初にマスクして走れって言った山中教授はもうマスク外してるのに+4
-0
-
3261. 匿名 2022/05/11(水) 20:48:43
>>41
かわいそう涙+6
-1
-
3262. 匿名 2022/05/11(水) 20:49:29
>>3230
あなた、よくそんなんで生きていられるね
もう、一生何かに怯えて暮らしていれば
+6
-3
-
3263. 匿名 2022/05/11(水) 20:49:41
>>3257
前々羨ましくないから大丈夫ですw+1
-0
-
3264. 匿名 2022/05/11(水) 20:50:08
>>3259
マスクつけられない体質って言えば余裕+3
-6
-
3265. 匿名 2022/05/11(水) 20:50:18
>>3258
自分が防護衣着ていれば安心よ+2
-4
-
3266. 匿名 2022/05/11(水) 20:50:24
各国がマスク義務解除後も、世界的な感染者数は右肩下がりなのに
アメリカがちょっとリバウンドしただけでマスクをしないからだとすぐに報道
マスクつけてる韓国や台湾が世界トップクラスの感染爆発を起こしてても、マスクをしてる事はスルー+6
-0
-
3267. 匿名 2022/05/11(水) 20:50:44
実際マスク無しで話した知人は一人だけだし
(私はマスク無しではおしゃべりはちょっと無理って伝えて離れた)
マスク無しでお話しするのは
蔓延中は外でもお互い気遣い合う気がするけどなぁ
暑くなったら外じゃおしゃべりしないし
室内ならマスクだし
運動してたりマスクしてない人には近づかないように気を使ってる
海外みたいにマスク全部無しは日本はならないと思う+3
-5
-
3268. 匿名 2022/05/11(水) 20:50:58
>>3263
じゃあ死ぬまでマスクゴッコしてね+1
-3
-
3269. 匿名 2022/05/11(水) 20:51:39
>>3246
マスク効果あるの?+1
-1
-
3270. 匿名 2022/05/11(水) 20:52:37
>>3269
デメリットしかないよ+3
-2
-
3271. 匿名 2022/05/11(水) 20:52:38
>>3268
りょーかい!+0
-0
-
3272. 匿名 2022/05/11(水) 20:53:08
>>3228
下がらないという根拠は?+2
-0
-
3273. 匿名 2022/05/11(水) 20:53:12
ブスはマスク、私のような美人はノーマスクでいいでしょ
みんな幸せよ+2
-2
-
3274. 匿名 2022/05/11(水) 20:53:23
>>3157
渋谷なんて広範囲で特定出来るわけないじゃん。都内の人じゃないでしょ。
+1
-0
-
3275. 匿名 2022/05/11(水) 20:54:21
>>2949
ギリギリ東京だよ。+0
-0
-
3276. 匿名 2022/05/11(水) 20:54:31
歯医者で働いてて、患者さん結構来るけど一度もコロナ感染してない。通ってくれる患者さんの中にはコロナに感染してたからキャンセルしますって人も結構いるから、いつもヒヤっとするけど
やっぱマスクのお陰でかからず済んでいると思う。+4
-0
-
3277. 匿名 2022/05/11(水) 20:54:42
自分ひとりで車運転してる時だってしてるんだから。+0
-0
-
3278. 匿名 2022/05/11(水) 20:54:45
>>3264
やっぱり嘘くさい。+2
-0
-
3279. 匿名 2022/05/11(水) 20:54:46
>>3267
義務解除してもマスクを外さないだろうといわれてた韓国で、かなりの人数マスク外してるけどね
日本もそうなると思うよ+1
-0
-
3280. 匿名 2022/05/11(水) 20:55:10
>>2912
屋内でもいいんだ?
でも店側がマスク推奨してるなら、つけるしか無いよね?+1
-0
-
3281. 匿名 2022/05/11(水) 20:55:25
>>3259
乗ってないんじゃない?+0
-0
-
3282. 匿名 2022/05/11(水) 20:55:40
>>546
分かるー。皇居ランナーは密だから必要。平気で人の近くスレスレ走る。
マスク無しでいいのは距離を取れる時。+4
-3
-
3283. 匿名 2022/05/11(水) 20:55:47
外国人観光客受け入れのためにとしか思えなかった。+2
-0
-
3284. 匿名 2022/05/11(水) 20:55:55
関係ないけど明日12日に国民投票法改正案が審査される
これが通れば憲法改正も強引に通される
そして自民党の憲法改正案が認められるとやばい
もはや国民に人権はなくなる![「屋外ではマスクをはずす」 東京都医師会が提案 段階的な感染対策解除も求める]()
+5
-1
-
3285. 匿名 2022/05/11(水) 20:56:14
>>2674
いつも思うんだけど、マスクに信用が厚い人って、勿論外す時は表面触らないように気をつけて、一日に何度も交換してるってことよね?
じゃないと、マスクをつけたり外したりするたびに、あちこちにウィルスや雑菌が付着。
よっぽど不衛生…![「屋外ではマスクをはずす」 東京都医師会が提案 段階的な感染対策解除も求める]()
+9
-1
-
3286. 匿名 2022/05/11(水) 20:57:04
>>595
皇居の周りのせっまい歩道でランナーに囲まれる恐怖を味わってみてほしい+1
-0
-
3287. 匿名 2022/05/11(水) 20:57:17
>>3285
反マスク活動家か、知能低そう、てか知能なさそう+4
-3
-
3288. 匿名 2022/05/11(水) 20:57:18
>>3280
そうなんだよね。店側のそういうのがうっとうしいんだよ。店も行政に言われた仕方ないんだろうけど、何か言われたらら熱中症が怖くて、ぐらい言ってもいいと思う。+0
-2
-
3289. 匿名 2022/05/11(水) 20:57:19
マスク信じてる人達は、なにをいっても聞かないからw
一生つけてればいい、ノーマスクの人に対し嫌がらせしないで+8
-2
-
3290. 匿名 2022/05/11(水) 20:57:49
息子のクラスにマスク長時間付けれないって子がいるけど、その子にちゃんと周りが気を遣ってマスクをしているみたい。その子は持病があるみたいで万が一コロナに罹ったら大変だからって。優しいクラスだなと思ったよ。
もちろん体育の時とかは外したり調整してるみたいだけどね。+0
-0
-
3291. 匿名 2022/05/11(水) 20:58:17
>>3232
マスクしたいならずっとしてたらいいじゃん?って言ってる人もいるし
マスク外すな!無症状感染者がー!って人もいるからね
+0
-0
-
3292. 匿名 2022/05/11(水) 20:58:20
>>3287
でたよ。そうやってレッテル貼るなら、マスクが清潔かどうかをデータ付きで説明してみてよ。+2
-1
-
3293. 匿名 2022/05/11(水) 20:58:22
>>3259
新幹線や高速バスでも何も言われなかったよ
私が清潔美人だったからかなぁ+2
-3
-
3294. 匿名 2022/05/11(水) 20:58:56
馬鹿が「やっとマスクなしやったー!!」ってぬか喜びしてるけど密ではマスクつけてね。医師会が言ってるのはそういう事だよ。
さっきからこれコメントしてるけど通じない馬鹿多すぎ。+4
-4
-
3295. 匿名 2022/05/11(水) 20:59:02
>>3293
もうええで。+2
-0
-
3296. 匿名 2022/05/11(水) 20:59:23
>>2833
こんな人本当に多い。
怖い、怖いと子どもに習い事休ませたり、移動のたびにアルコール吹きかけたり。
情報源は不安を煽る反日ワイドショーだけ。
そんなに心配なら厚労省のコールセンターに問い合わせて子どもの重症化率聞いてみればいい。
+5
-1
-
3297. 匿名 2022/05/11(水) 20:59:34
>>3293
煽りネタとしてはいまいちかな。+0
-2
-
3298. 匿名 2022/05/11(水) 20:59:43
>>3286
強迫性障害+1
-3
-
3299. 匿名 2022/05/11(水) 20:59:50
>>3276
+0
-0
-
3300. 匿名 2022/05/11(水) 21:00:05
>>1
全部外すのは反対だけど、これには賛成。
呼吸数が多い子供には酷だし、体にも異常が起きる。
これから暑くなるし、熱中症で倒れるもん。、+2
-0
-
3301. 匿名 2022/05/11(水) 21:00:07
>>3270
ほんとそれ。汚ったないよ。+6
-1
-
3302. 匿名 2022/05/11(水) 21:00:14
>>1
要は口を開く、声に出すってことをしなければ自粛は必要がない
・チャットアプリで会話する
・スマホやタブレットのメモ帳に書いて会話する
・紙とペンで会話する
・ジェスチャーで会話する
・手話で会話する
これを実践すればいい
まあ席やくしゃみは突然出たりするからマスクはしておいたほうが安全だけど
上記のように喋らない、口を閉じていても声を出すと飛沫が漏れるから声に出さないを徹底すればそもそも自粛は必要なかった
医者ってのはわいせつだの盗撮だのそんなことばっかりやってるから、そんな簡単なことにも気づけ無い
本当に医者ってのは金食い虫の役立たずだわ
「服をまくって下さい」専門学校で新入生の健診中に18歳女子学生2人にわいせつ行為か 44歳医師を逮捕(東海テレビ) - Yahoo!ニュースnews.yahoo.co.jp名古屋市西区の専門学校で、新入生の健診中に女子学生の身体を触るなどわいせつな行為をしたとして、医師の男が逮捕されました。 逮捕されたのは、名古屋市天白区中平の医師・岩崎博文容疑者(44)です。
女性患者3人盗撮、容疑で医師の男3度目逮捕 手術着はだけるスロー動画も(京都新聞) - Yahoo!ニュースnews.yahoo.co.jp京都府立医科大付属病院(京都市上京区)で医師が手術中に女性患者らを盗撮したとされる事件で、京都府警下京署は10日、中学生を含む女性患者3人にも盗撮行為をしたとして、児童買春・ポルノ禁止法違反(製造
+1
-1
-
3303. 匿名 2022/05/11(水) 21:00:39
>>3294
ほんとこれ+3
-1
-
3304. 匿名 2022/05/11(水) 21:00:42
>>3297
デブスはマスク強要されるんじゃない?
知らんけど+1
-2
-
3305. 匿名 2022/05/11(水) 21:00:45
>>3272
先に答えなさいよ。質問に質問で返すんだ。+0
-2
-
3306. 匿名 2022/05/11(水) 21:01:13
ヨーロッパの去年の超過死亡
マスクしてない国といつもマスクしてる国、見事に綺麗に結果出てるよ
マスクしてる方がたくさん死んでる
いい加減目を覚まさないと、コロナでも死ぬ他でも死ぬ、病人ばっかり増えるだけ+16
-1
-
3307. 匿名 2022/05/11(水) 21:01:22
>>3254
付けてることで誰にも迷惑かけないのにね+1
-1
-
3308. 匿名 2022/05/11(水) 21:01:26
>>41
してなかったらしてなかったで文句言うくせに、付けてるとこれだもんな┐(´д`)┌
生きづら〜+1
-2
-
3309. 匿名 2022/05/11(水) 21:01:32
>>3272
こういうデータ、いろんな州や国で出してるよ
いくらでも出てくる![「屋外ではマスクをはずす」 東京都医師会が提案 段階的な感染対策解除も求める]()
+9
-0
-
3310. 匿名 2022/05/11(水) 21:01:35
>>3290
濃厚接触者対策じゃなくて?
マスクってコロナに効果あるの?+0
-1
-
3311. 匿名 2022/05/11(水) 21:01:47
>>3287
ん?
普通に考えて、長時間付けたマスクは清潔ではないよね?知能が低いとか、ちょっと何言ってるか分からない。+5
-1
-
3312. 匿名 2022/05/11(水) 21:02:40
>>3307
ウイルスが見えていたらわからんよ。マスクを触ったその手でお金触わってそして渡すんだよ。かえって迷惑かも。+2
-2
-
3313. 匿名 2022/05/11(水) 21:02:51
>>3294
マスクはいいから、さっさと5類に下げろ+11
-1
-
3314. 匿名 2022/05/11(水) 21:03:21
>>3276
歯医者なんてマスク無しどころかモロ口の中覗き込むもんね
自分がマスク付けることによって感染防げてるかもしれないのなら、他人がマスク外そうが自分が付けてさえいれば大丈夫なんだからマスク外すなとやかく言う必要ないよね+5
-1
-
3315. 匿名 2022/05/11(水) 21:03:27
>>3214
幼稚だよな+1
-0
-
3316. 匿名 2022/05/11(水) 21:03:33
このトピ
以前から室内でもマスクをしない人の書き込みが
多くあってかなりビビる
自分の周りの人達は気遣いしてくれる人達だったんだと
改めて感謝しようと思いました
マスク無しは思想がわかりやすくて
お互いに凄くいいね+6
-3
-
3317. 匿名 2022/05/11(水) 21:03:44
>>3313
ほんとそれ。余計なことを言わないでさっさとそれをしたらいい。そしたら自ずとみんな外すよ。+5
-1
-
3318. 匿名 2022/05/11(水) 21:04:09
>>1
金まみれ権力まみれの東京都医師会の言うこととはまったくもって信用できず逆をいったほうがいい。つまりマスクはしたほうがいい+3
-0
-
3319. 匿名 2022/05/11(水) 21:04:32
>>3279
韓国と一緒にするなんて
いくらなんでも日本に失礼すぎる+0
-3
-
3320. 匿名 2022/05/11(水) 21:04:46
>>3308
あなた小学生でしょ?+0
-1
-
3321. 匿名 2022/05/11(水) 21:04:52
>>3318
え?それ言うなら屋内ではまだしておけって言ってるから、やっぱり外してもいいんだよ。+1
-1
-
3322. 匿名 2022/05/11(水) 21:04:58
>>3264
飛行機は無理やろ+4
-0
-
3323. 匿名 2022/05/11(水) 21:05:36
>>248
私女捨てかけてるからマイナスだなー
リップ代浮くし二重顎隠せるし口元出てないと安心する
あと噛み締め癖あって顎が凝るので、よく舌回しとか顎の前後運動とかやってるから人に隠れてやりやすかった+2
-0
-
3324. 匿名 2022/05/11(水) 21:06:15
>>1182
わかる!すれ違う時に限って咳やくしゃみするんだよ+4
-0
-
3325. 匿名 2022/05/11(水) 21:06:24
>>3316
人目気にしてるだけで外したい人もいると思うよ。
そもそもマスクってコロナに効果あるの?+8
-1
-
3326. 匿名 2022/05/11(水) 21:06:27
マスクしないって人はしなくていいけど、コロナに感染して重症化しても病院行かないでね
ちゃんと対策してるのに罹ってしまった人優先で診てほしいから+2
-6
-
3327. 匿名 2022/05/11(水) 21:07:06
>>1
でもガル民のブサイクババア面なんか公害のゲロ害悪そのものなんだからガル民はマスク義務化でOK+1
-1
-
3328. 匿名 2022/05/11(水) 21:07:11
>>3287![「屋外ではマスクをはずす」 東京都医師会が提案 段階的な感染対策解除も求める]()
+1
-0
-
3329. 匿名 2022/05/11(水) 21:07:34
>>7
夏は嬉しいけど、マスク外してたら文句言ってくるやつ出てきそうで嫌だな+3
-0
-
3330. 匿名 2022/05/11(水) 21:07:56
>>3316
全てに感謝をマスクに感謝を+1
-2
-
3331. 匿名 2022/05/11(水) 21:08:17
>>1
医師会とWHOの言うことなんか誰も聞かないよ。
こいつらの言うことを聞く連中は売国非国民だからね。+0
-0
-
3332. 匿名 2022/05/11(水) 21:08:45
前どっかの議員が飛行機で断固マスク付けなくてニュースになってたよね
ここでスーパーやコンビニでまマスクしないって言ってる人もそんなかんじでやばい人なんだろうな+1
-2
-
3333. 匿名 2022/05/11(水) 21:09:11
>>3326
百歩譲ってマスクの強要なら鼻で笑えるけど、あなたに病院行くなと言う権限は一切ないからね。+2
-1
-
3334. 匿名 2022/05/11(水) 21:10:29
>>3316
ほんとそうおもう
+1
-2
-
3335. 匿名 2022/05/11(水) 21:10:56
>>3328
これ完璧にしてる人は一体何人いるをだろね
私は正直できてない+8
-1
-
3336. 匿名 2022/05/11(水) 21:12:11
せっかくクソみてーな飲み会も集まりもなくなったのに・・・・
一生コロナで騒いでてくれ~~~+5
-0
-
3337. 匿名 2022/05/11(水) 21:12:16
>>3332
コロナ前はノーマスクが普通だったんですよ
マスク必須の今の世の中が異常なんです+4
-3
-
3338. 匿名 2022/05/11(水) 21:12:50
とにかく子供ははずさせて
暑くて死んじゃう+7
-0
-
3339. 匿名 2022/05/11(水) 21:12:58
>>3335
私も。毎日新しいマスクにしてるだけだよ。強者は何日も同じのを使うんだよ。めっちゃ不衛生。+5
-1
-
3340. 匿名 2022/05/11(水) 21:13:18
>>1
「ソーシャルディスタンスを保てる屋外では、マスクをはずす」
ということは裏を返せば
<マスクを外してOKな条件>
熱中症の恐れがある【気温湿度が高い日】の【屋外】で【ソーシャルディスタンス2m以上を保てる時】
ってことだね。
その時だけはマスクを外していい。
それ以外は当然ダメ。
+3
-0
-
3341. 匿名 2022/05/11(水) 21:14:30
>>3340
なんでそんなこと言われなきゃいけないんだろうね。マスクの効果がないことなんて分かってるのに。+2
-1
-
3342. 匿名 2022/05/11(水) 21:14:33
マスクを装着すると飛沫の一部をマスク内部に留めることができます。しかしある程度の飛沫やエアロゾルは通します。呼気吸気はほぼ通します。
マスクの効果は飛沫の量を抑え、飛距離や放出スピードを抑制することですが、マスクそのものの状態や品質そしてマスクの装着具合や装着時間によってその効果も落ちます。実験のように確実に装着していても飛沫を100%抑え込めません。開封したてのマスクを何時間で交換してますか?何時間も同じマスクしてませんか?そんなに頻繁に交換して使うほど対価はありますか?マスクはほんの一部の経路のほんの一部を抑えているだけで、かえって熱中症や雑菌の繁殖等リスクの方が大きいです。
マスクの小さい効果と、不経済不衛生不健康のリスクと天秤にかけてください。
どれだけ無駄なことをしているか考えてください。+2
-1
-
3343. 匿名 2022/05/11(水) 21:14:37
>>3340
なぜ岸田はノーマスクOKなんですか?![「屋外ではマスクをはずす」 東京都医師会が提案 段階的な感染対策解除も求める]()
+5
-1
-
3344. 匿名 2022/05/11(水) 21:15:08
>>3242
明日病院行く予定です。
飲み込むときにすごい喉が痛い。乾燥したとかそんなレベルじゃなくて。+1
-0
-
3345. 匿名 2022/05/11(水) 21:15:38
介護だけど、いつまでマスクしなきゃいけないの?
高齢者って寒がりだから、エアコンガンガン効かせることもできないし、たまんないよ+2
-0
-
3346. 匿名 2022/05/11(水) 21:15:50
外国人観光客入れるから屋外OKにするのかな。
外国人観光客はマスクしない人が多そうだし、
そしたら色々と揉めるだろうし。
+2
-0
-
3347. 匿名 2022/05/11(水) 21:17:00
>>3344
それ、ストレスかも。私も去年まで毎年なってたわ。でもあなたとわたしは当然違うし、明日病院に行くもんね。お大事に。+1
-0
-
3348. 匿名 2022/05/11(水) 21:17:12
>>2953
マスク外す人がいないことが遅れているの?
意識の違いだと思うよ
+1
-1
-
3349. 匿名 2022/05/11(水) 21:18:35
遅れてるとか地方だとか馬鹿にしてるヤツらなんなの+0
-0
-
3350. 匿名 2022/05/11(水) 21:19:07
>>2953
東京というか、日本が脱マスクから取り残されている感じ+1
-0
-
3351. 匿名 2022/05/11(水) 21:20:21
>>1
こういうのって世の中の99%以上を占めるブスほどマスク外したがるよね。
だいたいブスってのは目立ちたがり屋でしゃしゃってくるんだから。
いやいや、あんたブス自覚してマスク外すなよって話。
美人は控えめだしマスク外すと男の性的好奇心にさらされるのが嫌だからマスクを外したがらない。
まったく世の中ってのは分かりやすく良く出来てるわ。+4
-15
-
3352. 匿名 2022/05/11(水) 21:20:45
>>3306
どのデータみても、ワクチンもマスクも悪影響しか出してないよね
+10
-1
-
3353. 匿名 2022/05/11(水) 21:21:18
>>3346
外人って航空機の中ではマスクもつけてくるのかな?
日本にきたら外してるのかな
国内便のCAはゴーグルまでしてるときいたけど+3
-0
-
3354. 匿名 2022/05/11(水) 21:21:22
>>3339
うちの社長が、ガチガチのコロナ脳の人で、不織布以外のマスクをしてる人、鼻出しマスクしてる人のことをいちいち注意して回ってたんだけど、ある時「不織布マスクはお金がかかって大変」という話を社員がしているのを聞いて、こう言った。
「え?毎日変えてるの?」
……………は???+17
-0
-
3355. 匿名 2022/05/11(水) 21:21:44
>>3324
いるいる!あと少し我慢しろよ!って思う。せめて反対側向いてほしい
+3
-0
-
3356. 匿名 2022/05/11(水) 21:22:08
5月に入ってからマスク外し始めた。外歩いてる時と、平日の空いてる電車内も外してる。ジロジロ見られたり何か言われたことはないよ。みんなスマホに夢中だしね。+10
-3
-
3357. 匿名 2022/05/11(水) 21:23:08
>>3316
思いやりマスク
思いやりワクチン
これに疑問抱かない人多いって
この国。狂ってるぜw
+15
-2
-
3358. 匿名 2022/05/11(水) 21:23:33
>>3354
なんだよ、それ。やっぱりコロナばっかり怖がれるのはそういうことなのね。衛生観念もめちゃくちゃだし、思考停止して頭隠して尻隠さず状態じゃん。+6
-0
-
3359. 匿名 2022/05/11(水) 21:23:40
>>3354
ごめん、変換間違い
変えてるの→替えてるの+3
-0
-
3360. 匿名 2022/05/11(水) 21:23:45
>>3356
連休あけからノーマスクふえたよね!
よい傾向だよ(^ω^)+11
-2
-
3361. 匿名 2022/05/11(水) 21:23:52
>>3
妊婦で日中外マスクして動くの本当しんどい!賛成!+13
-0
-
3362. 匿名 2022/05/11(水) 21:24:53
>>3088
反マスクは嘘ばっかだね
マスクしてる人の方が圧倒的に多いから+2
-2
-
3363. 匿名 2022/05/11(水) 21:24:56
マスクをしてない人間は頭のおかしい人ってさ
ローマ法王の前でマスクをしない岸田総理に言いなよw+6
-1
-
3364. 匿名 2022/05/11(水) 21:25:02
>>3351
無理くりすぎるよ。自己愛拗らせてる人が言うことに似てる。+1
-0
-
3365. 匿名 2022/05/11(水) 21:25:14
友人が誰もいないような河原で犬の散歩をしていたら、知らないおばさんが近づいて来て「マスクくらいしなさいよ!」と吐き捨てる様に言って、去って行ったんだって。
友人はめちゃくちゃ驚いたと言ってたよ…
河原で単独で犬の散歩のタイミングなら、マスクいらなくない!?+16
-0
-
3366. 匿名 2022/05/11(水) 21:25:20
>>1019
なんか思ってたんと違ったw
でも素敵な男性だったんだね☺️♡+2
-0
-
3367. 匿名 2022/05/11(水) 21:25:46
>>3343
いつになったら更新するんだろ![「屋外ではマスクをはずす」 東京都医師会が提案 段階的な感染対策解除も求める]()
+0
-0
-
3368. 匿名 2022/05/11(水) 21:25:52
夏は暑いから外したいけど、顔見せるのなんだか恥ずかしい。
夏以外は着けようかな。いろんな菌もらいたくないし。+2
-2
-
3369. 匿名 2022/05/11(水) 21:26:03
>>3259
新幹線は何も言われなかったな。だって義務化したら駅弁売れなくなるじゃん笑+4
-0
-
3370. 匿名 2022/05/11(水) 21:26:07
>>3351
いいきれてるのがスゴイ+0
-1
-
3371. 匿名 2022/05/11(水) 21:26:26
>>185
>>2145
都内住み、私もマスク外してる人まず見なかったけど、先週電車の中で目の前に座ってる女性がマスク外してて一瞬ギョッとしたw
食事の時や自宅以外で、同じ空間にいる人がマスクしてるのが当たり前になってたんだよね。+3
-3
-
3372. 匿名 2022/05/11(水) 21:26:37
電車降りた瞬間マスク外して颯爽と改札を駆け抜けてったお姉さんいたから思わず目で追ってしまったw
私も明日から1人の時はマスク外す!+10
-1
-
3373. 匿名 2022/05/11(水) 21:27:12
>>3354
自分も、お爺さんから「汚れてないから」と言われた事ある
日またぎマスク
おじ(い)さんだけだと思うけど、マスクつけたらOKという人がいる+1
-0
-
3374. 匿名 2022/05/11(水) 21:28:06
1人で歩いてる時とかはもうしてない。
お店入ったり、人といる時はしてるけど…
1人で屋外だよ?新鮮な空気吸わせてくれ。+8
-0
-
3375. 匿名 2022/05/11(水) 21:28:34
>>3367
こわいよね+0
-0
-
3376. 匿名 2022/05/11(水) 21:28:38
>>3351
ドラマ「やんごとなき一族」の義姉の口調で読むと、めっちゃオモシロいw+2
-0
-
3377. 匿名 2022/05/11(水) 21:28:39
>>12
やだ。私は外すよ。
つけたいならどうぞー+13
-6
-
3378. 匿名 2022/05/11(水) 21:29:10
超美人の妹がマスク外で外して歩いてると、まぁ前から歩いてくる人がガン見しまくり。
マスク外すとすごい見られるから嫌なんだけど暑いし本当辛い、みんな外で外してないの暑くないの?って言ってた。+3
-1
-
3379. 匿名 2022/05/11(水) 21:29:28
>>3369
弁当食べる時は何も言わないじゃん。それいったらすべての飲食店も店を閉じないといけないのよ。
たまに車掌さんが回ってきた時は何も言われなかったの?+1
-0
-
3380. 匿名 2022/05/11(水) 21:29:31
今日満員電車乗ったら暑かったな・・・鼻と口が覆われてるの本当しんどい。全員無言なんだから外してもいいよね?って思うけど、チキって外せないのが情けない+2
-0
-
3381. 匿名 2022/05/11(水) 21:29:50
>>2508
間に合うよ。
くしゃみって出そうになって一息吸ってから出るから普通は手で押さえるの間に合う。かなりの高齢者でも無いのに間に合わないって大丈夫?なレベル。
手で押さえた後はその手をハンカチで拭けば良いし、それができないなら日常生活不安なレベル。+1
-2
-
3382. 匿名 2022/05/11(水) 21:30:27
>>2913
自分が不快だからマスクつけろと???
他人を思い通りに動かそうとすんの止めた方がいいよ。ストレス溜まりやすくなって早死にするよ。コロナより怖いと思うわ。+3
-3
-
3383. 匿名 2022/05/11(水) 21:30:38
コロナ補助金不正受給で1,000億稼いだ泥棒医師会がそういうならマスク逆にしておく
それだけ+1
-1
-
3384. 匿名 2022/05/11(水) 21:30:39
>>3373
うわ、もう感染源じゃん。早く外したほうがいいよね。+1
-0
-
3385. 匿名 2022/05/11(水) 21:30:40
>>1218
2歳って臨機応変とか通じないからお外イコールマスクで身につくと親が急に外そうかって言ってもイヤイヤされて外してくれない時よくある。
私の子今2歳なんだけど最近暑くなってきたから公園で外してあげようとすると拒絶される時ほんとよくあって困ってる。
上着とかも暑いから脱がせようとすると頑なに脱ぐの嫌がったり。
無理強いしたらギャン泣きされてその場から動けなくなる面倒さもあるし、でも外してあげたいから様子見計らってタイミング良くサッと取ろうと親なりに頭の中試行錯誤してたり色々事情がある場合もある。
マスクしてなかったら色々言われるしやっとの思いでマスクを覚えさせたのにしてたらしてたで今度は可哀想と簡単に言われ、ほんとコロナ禍って人の目が面倒くさい。
+1
-0
-
3386. 匿名 2022/05/11(水) 21:30:45
韓国までマスクを外しだしてるのみたら、さすがの日本の若者も反発心でてくるんんじゃない
この国なんかおかしいよって+2
-0
-
3387. 匿名 2022/05/11(水) 21:31:02
>>2
まあコロナ以前からコンプレックス隠しでマスクしてる人は沢山いたからそれは好きにしたらいいよ
マスク婚活とかもあったし
でも着用押し付けはしないでね+2
-0
-
3388. 匿名 2022/05/11(水) 21:31:08
>>3354
こんな奴にマスクは不織布にしろとか鼻出すなとか、言われるのメッチャ腹立つ!!!
でも恐ろしいことに周りよく見たら、黄ばんだりしてるの付けてる人結構いるんだわ、これが。+1
-0
-
3389. 匿名 2022/05/11(水) 21:31:10
>>3367
どうなってんの?+2
-0
-
3390. 匿名 2022/05/11(水) 21:31:12
>>3351
(笑)+2
-0
-
3391. 匿名 2022/05/11(水) 21:31:21
マスクって本当に意味あんのかな?マスクばっちりつけて毎日生活してたのにオミクロンに感染した。高熱二日間に喉なんて激痛でしんどすぎた。マスクしていても感染するならもうマスクしたくない。+5
-0
-
3392. 匿名 2022/05/11(水) 21:31:21
みんな外で暑くないの?マスク+4
-0
-
3393. 匿名 2022/05/11(水) 21:31:22
>>3383
短絡的すぎるよ。屋内ではまだしておけ、ということは屋内で外せばいいんだよ。+1
-0
-
3394. 匿名 2022/05/11(水) 21:32:16
親が陽性の場合 子供に症状なくても修学旅行参加できませんか。 友達が多分陽性で‥今はホテルに隔離しに行ってますが その子の子供が来週の修学旅行にいけるか心配してます‥やっぱり無理かな‥+0
-0
-
3395. 匿名 2022/05/11(水) 21:32:54
還暦の母がニュース見て「明日から自転車乗ってる時は外してもいいよね?」って言ってきた。「自転車の時もつけてたの?しなくていいんだよ!」って言ったけど、ハッキリ示さないと家以外は全部付けるものだって安直に思う人たくさんいるね。苦しい思いしてても外そうとしないのが怖い。+8
-0
-
3396. 匿名 2022/05/11(水) 21:33:13
>>3381
普通手で口元を押さえるよね
さらに人のいない方を向いて
おっさんは手すら押さえない人が多いけど+1
-1
-
3397. 匿名 2022/05/11(水) 21:33:26
>>3385
うちの子はその逆でどこへ行くにもマスクさせないでいたから年少さんで幼稚園入ったけど毎日マスクとっちゃうみたい。+0
-1
-
3398. 匿名 2022/05/11(水) 21:33:32
>>3394
学校に確認すれば?+0
-0
-
3399. 匿名 2022/05/11(水) 21:33:35
>>3356
都内ですか?+2
-0
-
3400. 匿名 2022/05/11(水) 21:34:30
>>3394
濃厚接触者は陽性者との最後の接触から7日間って言われたよー+0
-0
-
3401. 匿名 2022/05/11(水) 21:34:47
暑いから夜外して歩いてたらみんなマスクしててジロジロ見られたよ…気のせいだと思いたかったけど、隣マスク外さないで歩いてた彼氏に、みんなお前の顔見てるよなって言われた。やっぱノーマスクはまだ早いのか…+11
-1
-
3402. 匿名 2022/05/11(水) 21:35:03
>>3399
千葉です〜+0
-0
-
3403. 匿名 2022/05/11(水) 21:35:36
>>86
一部の女子中学生とか学生は、コロナ以前から一年中ずっと付けてる。+0
-0
-
3404. 匿名 2022/05/11(水) 21:36:09
わたし...キレイ?+0
-0
-
3405. 匿名 2022/05/11(水) 21:36:10
>>34
自意識過剰、誰もあなたの顔に期待してないよ。+2
-0
-
3406. 匿名 2022/05/11(水) 21:36:11
>>3402
私都内住みだけどめちゃくちゃ見られると思うんだけど。羨ましい。+1
-0
-
3407. 匿名 2022/05/11(水) 21:36:29
>>3401
増えてきてるから大丈夫よ。舐められないオーラを出しておくことは強くお勧めするけどね。+9
-1
-
3408. 匿名 2022/05/11(水) 21:36:30
>>3360
自分もマスク無しで(耳にはかけてる)自転車乗ってるんだけど、前から歩いてくる人がサッとマスク下にずらしたりするのたまにあるんだよね。その人が「あ、外してもいいのか」って思えたきっかけに自分がなってたら嬉しいな。+5
-0
-
3409. 匿名 2022/05/11(水) 21:36:53
まともな人はマスク外し始めると思うんだけど、マスク警察はどうするんだろう?
みんなに吠えて、人から逃げて生きてくのかな。+3
-2
-
3410. 匿名 2022/05/11(水) 21:37:09
>>3401
俺も私も外そうかな、という視線も当然あると思うわ。+13
-1
-
3411. 匿名 2022/05/11(水) 21:37:13
>>3373
この前公園のベンチで休んでる爺さんのマスクが黄色いタンみたいな色してた。不衛生すぎる+2
-0
-
3412. 匿名 2022/05/11(水) 21:37:18
>>3340
そもそも「あまり周りに人が居なくて無言の時はマスクは意味ない」とも言ってるから寒い時も涼しい時も、「屋外で密じゃなければ」外して良いんだよ+4
-0
-
3413. 匿名 2022/05/11(水) 21:37:25
>>3401
きっとあなたがあんまり可愛いから皆ジロジロ見ちゃっただけよ+9
-1
-
3414. 匿名 2022/05/11(水) 21:37:43
>>3409
すでに自分からも逃げてるからね。+0
-0
-
3415. 匿名 2022/05/11(水) 21:37:59
>>3316
友達といる時は屋内でもマスクしてるけど
1人の時は黙って買い物したりするだけだからマスクしてない。
TPOによって使い分けてます+2
-0
-
3416. 匿名 2022/05/11(水) 21:38:41
>>3407
多分背も170ででかいので威圧感ありますw+1
-0
-
3417. 匿名 2022/05/11(水) 21:38:48
>>3413
追記:だって私もマスクなしで歩いてるけど視線なんか感じない…@38歳二児の母太め+6
-0
-
3418. 匿名 2022/05/11(水) 21:38:51
>>2416
マスクしないくていい
という部分だけが独り歩きしそう+2
-0
-
3419. 匿名 2022/05/11(水) 21:40:00
>>3416
だったら大丈夫だね。+0
-0
-
3420. 匿名 2022/05/11(水) 21:40:04
>>344
うちも田舎だけどこっちは朝からみんなマスクしてるよ
ゴミ捨てでパジャマにとりあえずマスクして来たみたいな人もいるし
外したいけど周りの目が気になるからしばらく着かなきゃだなぁ
田舎まで広まるのは時間かかりそう+4
-0
-
3421. 匿名 2022/05/11(水) 21:40:14
普段外で少しおしゃべりする相手というと幼稚園のママ友くらいなんだけど、誰かと一緒のときはやっぱりマスクしないとダメよね?
+0
-0
-
3422. 匿名 2022/05/11(水) 21:40:53
>>3407
舐められないオーラww痛いよ+1
-2
-
3423. 匿名 2022/05/11(水) 21:40:56
>>3265
そんなやつおる?+0
-0
-
3424. 匿名 2022/05/11(水) 21:40:57
結局、マスク外して叩かれてた議員の方が正しかったんじゃん+2
-0
-
3425. 匿名 2022/05/11(水) 21:41:48
みんな外で密じゃないならマスク外して欲しい。+2
-0
-
3426. 匿名 2022/05/11(水) 21:41:56
>>3365
わーって大声出しながら追いかけたい😊+2
-1
-
3427. 匿名 2022/05/11(水) 21:42:17
>>3421
会話する時はマスクしてるなぁ。なんだかんだでやっぱりマナーだと思うし、お互い気持ちよく会話する為に一応ね。+3
-2
-
3428. 匿名 2022/05/11(水) 21:42:18
>>3422
なにいってるの?大事なことなんだけど、一生草を生やしていればいいわ。+2
-0
-
3429. 匿名 2022/05/11(水) 21:42:31
>>3421
その人がしっかり検温してるなら別に話しても良いんじゃない。
岐阜が感染事例を出してるけど「38度の熱があるのに会食」みたいなケースがめちゃくちゃ多いよ。
+0
-0
-
3430. 匿名 2022/05/11(水) 21:42:56
>>4
え、マスクしながらご飯食べてるんですか?+0
-0
-
3431. 匿名 2022/05/11(水) 21:43:30
暑いって感じると吐く息が(鼻息も)熱くなるから、マスクしてると滝汗かいちゃう
わかる人いる?
外だけでもはずしたい+2
-0
-
3432. 匿名 2022/05/11(水) 21:44:05
>>3421
自分が無症状でコロナ感染してる場合もあるからなぁ
潜伏期間中とかさ+1
-2
-
3433. 匿名 2022/05/11(水) 21:44:12
>>3424
詳細は知らないんだけどその人は屋外で尚且つ密じゃない場所でマスクしない事に拘ったの?
それとも屋内で尚且つ密な場所でマスクしない事に拘ったの?+0
-0
-
3434. 匿名 2022/05/11(水) 21:44:27
屋外どころか屋内でも外したいわ。ショッピングモールで買い物する時、服を合わせるのもコスメを見るのもマスクしてる姿が鏡に映ると萎えるー+5
-1
-
3435. 匿名 2022/05/11(水) 21:44:33
>>1133
自分のシャツの中(首元引っ張って鼻まで隠して胸でする)でするのが正解だと思ってる。
唾は飛ぶけど自分の服の中だし。
こうやって書くとウェ〜ッて思うけど、人に迷惑かけない一番の方法だと思う。
手でカバーは汚いし、二の腕部分でカバーってアメリカではいうけどカバーしきれてない。+3
-0
-
3436. 匿名 2022/05/11(水) 21:44:43
緑茶や紅茶とかカテキン多めのお茶こまめに飲めばコロナやらインフルやら抗ウィルス作用ありと読んだり聞いたことあるが
それならば学校や会社でも自分のタイミングでちょこちょこお茶飲ませてもらえたら色々流行らなくなるかな
換気もしつつ+3
-0
-
3437. 匿名 2022/05/11(水) 21:45:00
>>3326
じゃあなたは炎天下の中マスク外さないで熱中症になっても救急車呼ばないでね、って言われたらどう?+6
-1
-
3438. 匿名 2022/05/11(水) 21:45:02
>>3354
逆に、コロナの初期に紙マスクが手に入らなかったので布マスクを使ったけど、毎晩、洗って専用の鍋で煮沸消毒して干して使ってた
それでもそんなの意味あるのか分からないけど
その社長さんの例にしても、不織布マスクさえつけてたらプロテクターになるわけじゃないと思うんだけどな
スマホの滅菌とか社長さんしてるのかな?+1
-0
-
3439. 匿名 2022/05/11(水) 21:45:41
通勤中マスクの下で変顔するのができなくなるw+0
-0
-
3440. 匿名 2022/05/11(水) 21:45:44
>>3365
通報すればよかったのにー+0
-0
-
3441. 匿名 2022/05/11(水) 21:46:48
暖かくなってから不織布やめてガバガバ布マスクに移行した!次はノーマスクになったるで+1
-0
-
3442. 匿名 2022/05/11(水) 21:46:54
外ではもう外してる。暑くて無理。
コロナ流行ろうが健康は人は無症状だし関係ないね。+2
-0
-
3443. 匿名 2022/05/11(水) 21:47:28
屋内はいつまでマスクしなきゃいけないの。
我欲新鮮的空気ッッ!!!+2
-0
-
3444. 匿名 2022/05/11(水) 21:47:37
>>3433
それどっちでもよくない?マスクに意味はないんだから。+0
-0
-
3445. 匿名 2022/05/11(水) 21:48:39
マスクしてない人をジロジロ見るのは「マスク外してていいなぁ」って気持ちです。+5
-1
-
3446. 匿名 2022/05/11(水) 21:48:55
>>3379
警備員が度々巡回してたけど何も言われなかったよ。ていうか黙食がOKなら無言の方が余程低リスクだし問題無いと思うんだよね~+3
-0
-
3447. 匿名 2022/05/11(水) 21:49:45
>>3259
言われないよ
目は合うけどスルー+0
-0
-
3448. 匿名 2022/05/11(水) 21:49:46
ただの風邪扱いでもう良いよって人も多いけど、
ただの風邪で、
禿げたり、味覚障害が出たり、仕事辞めないといけなくなる程倦怠感も残らないし、
脳みそ20年も年取らないよなぁ。
感染したらしたで仕方ないって、簡単には思えないなぁ。
予防できるものなら予防しておきたいけど、一方通行の予防では効果薄そう。
お互いが予防していてしっかりとした効果が発揮できることなんじゃないのかな。
これって、安易に
屋外=マスク不要 って都合の良いところだけ抜き取って解釈する人多そうだし、
そしたら、ちょっとドアや窓を開けただけの室内も、窓開いてるし屋外扱いで良いと解釈する人も出そうだし、
人が密集した屋外でもマスクしないで大騒ぎする人が出そうで怖い。+2
-3
-
3449. 匿名 2022/05/11(水) 21:50:05
>>1
屋外なんてもうとっくに外してるわ。
この2年間、濃厚接触者には何回もなったけど、コロナ含めてなにも感染してないで過ごせてるよ+2
-0
-
3450. 匿名 2022/05/11(水) 21:50:40
>>3392
暑くないのかなって不思議だよね
広大な野外の敷地のテーマパークとかでもマスクしてって書いてあったりするけど
全て感染予防対策風味を醸し出すためだけなんだろうな
しょーーーーーーーーもな+2
-0
-
3451. 匿名 2022/05/11(水) 21:50:59
>>3401
私はそういう人見るとカッコいいと思う
最近は屋外では鼻出してる、息苦しいし+9
-2
-
3452. 匿名 2022/05/11(水) 21:51:04
>>13
この間うっかり
自動販売機までマスク忘れたけどスカスカして
変な感じだったよ+3
-2
-
3453. 匿名 2022/05/11(水) 21:51:11
>>3446
そうだよ。でも矛盾を押し付けてきてるんだけど。そして新幹線に車掌さんじゃなくて警備員さんが回ってくるの?+0
-0
-
3454. 匿名 2022/05/11(水) 21:51:12
飛沫が気になるから飲食店の店員は今後もずっとマスクしろって言うならもう飲食店は利用するなと思う+10
-0
-
3455. 匿名 2022/05/11(水) 21:51:19
>>1
マスク意味ないって知ってた。+4
-1
-
3456. 匿名 2022/05/11(水) 21:51:29
>>3406
都内だとまだ難しいですよね。
屋外でも密集してるし。
+2
-2
-
3457. 匿名 2022/05/11(水) 21:51:54
今日夜誰も居ない道でマスク外したら、どこからかお花のいい匂いがしたよ。
こういうの久々に感じたな。
どこかの家のご飯の匂いとかはマスクしてても感じるけど、お花の繊細な匂いはマスク越しだと難しい。+14
-1
-
3458. 匿名 2022/05/11(水) 21:51:58
>>3322
それって人権侵害だよなぁ
+3
-1
-
3459. 匿名 2022/05/11(水) 21:52:13
>>3445
周りの目を気にしない強メンタル羨ましいと思ってみてるよ+6
-0
-
3460. 匿名 2022/05/11(水) 21:52:15
いい流れだと思う。
っていうか職場で鼻マスク禁止!絶対マスク着用って言ってるそばから、休憩中は誰一人マスクしてない。でも感染拡大なんかしてないから、この辺でマスク生活終わりの方向に行くのはいいと思う。地元では夏祭りも復活するみたいだし、楽しみがたくさんある世の中に戻ってほしい+16
-1
-
3461. 匿名 2022/05/11(水) 21:52:54
>>3434
美容室が、コロナ勃発の時や緊急事態宣言の時はマスク外してくれ(切りずらい?)って言われて、その後だいぶ経ってから「マスク着用お願いします」ってなって、逆じゃないか?と思った事ある+2
-0
-
3462. 匿名 2022/05/11(水) 21:53:10
>>3456
密集してない割と住宅街でもマスクしてる都内
もう、自分から変えてくしか無いなとマジで思ってる+5
-0
-
3463. 匿名 2022/05/11(水) 21:54:03
>>3453
横だけど、防弾チョッキみたいなの着てる警備員風?の大きめの男性が巡回してるよ。+0
-0
-
3464. 匿名 2022/05/11(水) 21:54:23
>>3448
同じ空間にいる人がもしかしたら三日前から変えてないかもしれないマスク1枚にどんだけの信頼を寄せてるの?
それなら自らのマスクを数枚重ねる方がまだ効果あるかもしれないじゃん
私不織布マスクは息苦しいから、今は絶対に布マスクしかしないよ
洗濯してるけどさ
冬にガチの咳風邪ひいた時だけ不織布マスクにする+4
-1
-
3465. 匿名 2022/05/11(水) 21:54:25
>>3457
わかる、香りや風って大事だなと思った。
公園とかでマスクしてるなんて悲しくなる。+3
-0
-
3466. 匿名 2022/05/11(水) 21:54:45
マスク外すとかふざけんな!!!!!!!!
今すぐ日本国憲法を改正して、マスク着用を国民の義務に加えろ!!!!
勤労!!
納税!!
教育!!
マスク着用!!!!
これがコロナ時代の日本国民四大義務だ!!!!!!+0
-7
-
3467. 匿名 2022/05/11(水) 21:55:18
アメリカなんてマスクみんなしてないよ
日本人は出る杭は打たれる国だからかな
コロナは目からも感染するのに口だけ隠して
メガネかけないのもマジおかしいよね😆
+7
-0
-
3468. 匿名 2022/05/11(水) 21:55:22
>>1893
よほど管理人さんがいていちいち注意してくるならともかく、そんな貼り紙無視していいと思うよ。+2
-0
-
3469. 匿名 2022/05/11(水) 21:55:45
やっぱ大人から変えてかないと、子供がいつまでも可哀想だわ。+6
-0
-
3470. 匿名 2022/05/11(水) 21:55:48
>>3456
都内でも普通に道は空いてません?
道まで混んでるなんて繁華街とか、駅前とかですよね
住宅地は人との距離保てますよ
相当狭い歩道とかなら別ですが。+5
-0
-
3471. 匿名 2022/05/11(水) 21:56:09
学校に子供3人見たいな田舎で
人が周りにすくなかったりしたらマスクしないのかな?+0
-0
-
3472. 匿名 2022/05/11(水) 21:56:12
>>3463
そうなんだ。どっちにしても何も言わないってどうなんだろう。JRに確認してみようかな。+0
-1
-
3473. 匿名 2022/05/11(水) 21:56:31
>>3454
飲食店は汚いところは飛沫どころの話じゃ済まない汚さだからね。
飛沫気にする人はどっちにしろ行かない方がいいよね。+3
-0
-
3474. 匿名 2022/05/11(水) 21:56:36
>>9
そうよ
マスク外したら露出狂よ+1
-1
-
3475. 匿名 2022/05/11(水) 21:57:13
>>3466
🤞+0
-0
-
3476. 匿名 2022/05/11(水) 21:57:21
>>3351
うんうん、そうだね、賢くて綺麗なあなたはずっとマスクつけてるといいよ。
可愛すぎて知らない人に惚れられても面倒だもんねぇ。
真夏のカンカン照りの蒸し暑い日も、写真撮影の時も、しわしわババアになっても、綺麗な顔を他人に晒さないように、ずーーーっとマスクつけてたらいいよ。+5
-2
-
3477. 匿名 2022/05/11(水) 21:57:26
>>3456
都内住みだけど家から目的地まで外の時は顎マスク→建物に着いたらマスク戻す→出た瞬間顎マスク
だよ
今んとこまだ何も言われたことない+6
-0
-
3478. 匿名 2022/05/11(水) 21:57:41
>>3463
その人が車掌さんじゃない???
切符を確認する人だよね?+0
-0
-
3479. 匿名 2022/05/11(水) 21:57:50
>>3465
おっさんの匂いとかのシャットダウンにはマスク最適なんですが、他の匂いも遮ってるんですもんね
お花のいい匂い、本当に久々に嗅ぎ嬉しくなりました+3
-0
-
3480. 匿名 2022/05/11(水) 21:58:03
>>3460
夏祭りとか花火大会とか、いいよねー。季節の風物詩。嫌な人は元々苦手なんだろうから来なきゃいいんだし。ビアガーデン行きたいな、転勤してきて行く友達居ないけど。+7
-0
-
3481. 匿名 2022/05/11(水) 21:58:25
来月から入国規制を緩和して外国人観光客を入れるんじゃなかった。
外国人は日本社会の同調圧力なんて気にしないから、法的拘束力のないマスク着用なんてするわけないよね。
しかも客として来るんだから、日本人も強く言えない。
そう言う環境で日本人だけに、距離の取れる外でもマスク着用を推奨するって無理ありすぎ。+2
-0
-
3482. 匿名 2022/05/11(水) 21:58:50
>>3467
大谷さんは日本の誇り+1
-0
-
3483. 匿名 2022/05/11(水) 21:58:52
>>3370
人は自信がない時ほど言い切るらしいよ+1
-0
-
3484. 匿名 2022/05/11(水) 21:59:24
>>3382
不快だと思ってるのはマスクつけたくない側じゃんよ。
何を曲解してるか分からないわ。
医師会は密ではマスクつけてねって言ってますよ。+2
-1
-
3485. 匿名 2022/05/11(水) 21:59:48
アホトピ
早よ堕ちろゴミ+0
-3
-
3486. 匿名 2022/05/11(水) 21:59:48
>>3483
わかる。モラ男ほどそうだもん。+0
-0
-
3487. 匿名 2022/05/11(水) 22:00:32
>>3467 それ同じ事ずっと思ってた+0
-0
-
3488. 匿名 2022/05/11(水) 22:00:34
>>3176
画像?+0
-0
-
3489. 匿名 2022/05/11(水) 22:00:48
>>3313
気が緩むとすぐ感染拡大するんだから出来ないに決まってるじゃん。+0
-1
-
3490. 匿名 2022/05/11(水) 22:01:23
>>3484
横だけど、ほんと余計なこと言ってくれたわ。
+2
-1
-
3491. 匿名 2022/05/11(水) 22:01:58
>>9
そもそも屋外で人が近くにいないのに、飛沫防ぐ必要ある?+3
-0
-
3492. 匿名 2022/05/11(水) 22:02:25
>>3489
緩んで風邪ぐらい引いた方がいいかもよ。ずっと張り詰めて脳にも酸素が行き渡らず、認知症なんてことになるほうが怖いよ。+3
-1
-
3493. 匿名 2022/05/11(水) 22:03:02
>>3491
横。屋内でも必要ないよ。意味ないのに。屋外ならなおさらだよね。+4
-0
-
3494. 匿名 2022/05/11(水) 22:03:26
換気しにくいエアコンの室内は
マスクして欲しいな
野外は避けられるから好きにして
他の方も書いてるけど熱中症予防と
ノーガードは違う+0
-1
-
3495. 匿名 2022/05/11(水) 22:03:34
>>3105
え?
そーなの?
知らなかった+0
-0
-
3496. 匿名 2022/05/11(水) 22:03:48
>>3472
電車は公的機関です。
乗客にマスク着用義務づけるなら、法律を用意しないと。+4
-0
-
3497. 匿名 2022/05/11(水) 22:03:50
>>3354
洗って使ってるんじゃない?実際お金バカにならないし、私も10~20回くらいは洗って使ってるよ。コロナ掛かったこともない+2
-0
-
3498. 匿名 2022/05/11(水) 22:03:53
>>3481
ガルって白人に憧れてる人多いから、憧れの白人がノーマスクで外を闊歩するのを目の当たりにしたら、マスクするのをカッコ悪く思い始めるかも。
+1
-0
-
3499. 匿名 2022/05/11(水) 22:03:58
>>1926
症状軽くてほとんどの人は重症化しなくなってきたし、コロナ感染者が増えたとしても蔓延防止とかももう出ないんじゃないかな+2
-1
-
3500. 匿名 2022/05/11(水) 22:04:07
>>3452
スカスカなそれが普通なんだよ〜早く慣れるといいね〜+4
-0
コメントを投稿する
トピック投稿後31日を過ぎると、コメント投稿ができなくなります。削除すべき不適切なコメントとして通報しますか?
いいえ
通報する